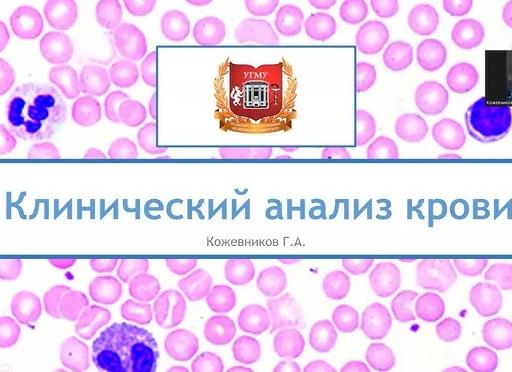
Какие показатели входят в общий анализ крови

Какие показатели входят в общий анализ крови
Наиболее распространенным видом исследования, который назначается при подозрении на любые заболевания, является общий анализ крови. Данная диагностика – обязательное условие прохождения медицинского осмотра.
Оглавление:
В анализ входят такие показатели, которые позволяют определить возможные нарушения патологического состояния пациента.
Подготовка к анализу и проведение процедуры
ОАК – самый распространенный и эффективный метод диагностики, который позволяет оценить состояние здоровья человека
Особой подготовки к сдаче крови для исследований не требуется. Единственным условием разве считается проведение процедуры на голодный желудок. В крайнем случае, после употребления пищи должно пройти около двух часов.
Обычно делают данный анализ утром. Кровь берут для исследования из безымянного пальца. Его прокалывают стерильным скарификатором. После того, как появляется кровь, лаборант набирает ее в сосуд небольшой пипеткой, которая имеет вид тонкой и длинной трубочки.
В исследуемом материале, используя микроскоп, подсчитывают количество клеток, также измеряют уровень гемоглобина. Неотъемлемой частью анализа является также выяснения скорости оседания красных телец крови.
Иногда кровь для анализа могут брать из вены на руке.
Расшифровкой анализа крови занимается специалист. Однако некоторые показатели крови после получения результатов может определить и пациент.
Расшифровка: норма основных показателей
Норма показателей ОАК варьируется в зависимости от возраста, пола и индивидуальных особенностей организма
К основным показателям исследования крови относятся:
Количество эритроцитов
Данные кровяные клетки питают кислородом ткани организма и удаляют из них углекислый газ, поэтому их показатель важен при расшифровке результата анализа. Количество таких клеток зависит от возрастного критерия и пола. Записываются эритроциты в бланке анализа следующим образом – десять клеток в двенадцатой степени на одну литру крови.
Нормальными показателями считаются:
- Мужчины — от 4 до 5
- Женщины – от 3,5 до 4,7
- Мальчики – подростки – от 4,5 до 5,3
- Девочки – подростки – от 4,1 до 5,1
- Дети в возрасте от шести до двенадцати лет – от 4 до 5,2
- Дети с двухлетнего возраста – от 3,9 до 5,3
- С полугода до двух лет – от 3,7 до 5,3
- Малыши в два месяца – от 2,7 до 4,9
- Один месяц — от 3 до 5,4
- Первые дни жизни – от 4 до 6,6
Лейкоциты
Лейкоцитарные клетки контролируют иммунную систему. Если в организм попадает инфекция, токсины или инородные тела, лейкоциты начинают бороться с ними. Формируются белые тельца в лимфатических узлах и костном мозге.
Лейкоциты делятся на следующие разновидности:
- Эозинофилы – помогают очищать организм от паразитов, токсинов, борются с раковыми клетками.
- Нейтрофилы – бывают незрелыми или палочкоядерными, а также зрелыми (сегментоядернымы)
- Моноциты – являются иммунными клетками, распознают в организме чужеродные вещества.
- Базофилы – мелкие клетки, которые способствуют иммунологическим реакциям.
- Лимфоциты – формируют иммунный ответ гуморального и клеточного плана.
Эти клетки имеют отличия в своей форме, размерах и функциях. Измерения лейкоцитов записывают: десять клеток в девятой степени на литр.
Лейкоциты – белые кровяные тельца крови, которые защищают человека от разных инфекций
Нормальный показатель лейкоцитов следующий:
- Для взрослых – от 4 до 9 клеток в поле зрения
- С шести до шестнадцати лет – от 4,5 до 13,5
- От двух до шести лет – от 5 до 15,5
- У детей – грудничков нормальным считается показатель лейкоцитов от 6 до 17,5.
Нормальными показателями в лейкоцитарной формуле считаются следующие уровни:
- Нормой нейтрофилов считаются показатели палочкоядерных (от одного до шести процентов) и сегментоядерных (от 47 до 72 %). Наиболее высокая концентрация нейтрофилов сегментноядерных в организме наблюдается у новорожденных и взрослых людей. Палочкоядерные могут колебаться от 3 до 12% в первые дни жизни ребенка.
- Уровень моноцитов в крови должен находиться в пределах от 3 до 11%.
- Базофилы в лейкоцитарной формуле не должны превышать 1%
- Эозинофилов в крови может быть от 0,5 % до 5%
- Для лимфоцитов нормой является показатель от 19 до 37%
Гематокрит
Исчисление данного показателя крови записывают в процентах, поскольку он показывает соотношение объемов крови и эритроцитов. Нормальным у пациентов мужского пола считается:
- До 45 лет – от 42 до 50%
- До 65 лет – от 39 до 50%
- Старше 65 лет – от 37 до 51%
Для женщин в том же возрасте показатель несколько отличается:
- До 45 лет – от 38 до 47%
- До 65 лет и старше – от 35 до 47%
Гематокрит у детей нормальным считается при таких показателях:
- Новорожденные – от 41 до 65%
- До трех месяцев – от 28 до 42%
- До полугода — от 31 до 41%
- До года – от 33 до 41 %
- До трёхлетнего возраста – от 32 до 40%
- К шести годам – от 32 до 42%
- До 12 лет – от 34 до 43%
- У девушек – подростков уровень гематокрита несколько ниже, чем у мальчиков.
Подробнее об общем анализе крови можно узнать из видео:
Тромбоциты
Данные кровяные клетки участвуют в свертывании крови. Их нормальный показатель становит от 180 до 320, умноженных на десять в девятой степени клеток на один литр.
Быстроту оседания красных телец обнаруживают двумя способами – методом Вестергрена и или Панченкова. Измеряется СОЭ в миллиметрах за час. Нормами считаются такие показатели:
- Женщины – до 20 мм за час
- Мужчины – до 15 мм
- Дети – от двух до десяти мм за один час
Эти нормы указаны для определения по Вестергрену, который является более чувствительным методом.
Основные причины отклонений от нормы, возможные заболевания
Отклонение от нормы основных показателей общего анализа крови – это тревожный признак, который может указывать на развитие в организме человека разный воспаленный, инфекций, заболеваний и даже новообразований.
Эритроциты
Если показатель эритроцитов превышает максимальную границу нормы, то это может свидетельствовать о таких патологиях как эритроцитоз или полицитемия. При этих заболеваниях развивается риск того, что красные тельца могут склеиваться и блокировать транспортировку крови по сосудам, что часто приводит к тромбозу.
Эритроциты это самые многочисленные клетки крови, которые выполняют очень важную функцию – транспортировку кислорода
Другими причинами такого отклонения являются:
- Эритремия
- Стеноз артерии почек
- Обезвоживание организма в результате диареи, рвоты, пониженного количества употребляемой суточной дозы жидкости
- Сердечная недостаточность
- Заболевания легких
Пониженный уровень эритроцитов говорит об анемии, при котором происходит недостаточное получение кислорода человеческим организмом. Основной причиной считаются патологические состояния кроветворной системы:
Причиной уровня эритроцитов ниже нормы может быть гемолиз – явление, когда кровяные клетки гибнут вследствие влияния токсинов и аутоиммунных болезней.
Лейкоциты
Повышаться лейкоцитарные клетки могут по физиологическим причинам или в результате инфекционно-воспалительных заболеваний. К физиологическим причинам относятся:
- Чрезмерные физические нагрузки.
- Период после вакцинации.
- Первые часы после употребления пищи.
- Середина второго-третий триместр беременности.
- Дни менструации.
Если такие факторы отсутствуют, причинами уровня лейкоцитов выше нормы могут являться следующие заболевания:
- Лейкоз
- Злокачественные новообразования
- Опухолевые процессы
- Обширные травмы
- Ожоги
Часто повышение лейкоцитов указывает на развитие воспалительного процесса в органе, например:
Понижение белых телец происходит по причине инфекционных и вирусных заболеваний. Среди возможных болезней выделяют:
Некоторые разновидности лейкоза, ревматические повреждения, лучевая болезнь и гиповитаминоз также влияют на понижение в крови уровня лейкоцитов. Стероиды и цитостатики, которые применяются для лечения опухолевых процессов, могут провоцировать снижение клеток.
Нейтрофилы
Если в организме повышается уровень нейтрофилов, это может указывать на такие состояния:
- Воспалительные процессы внутренних органов.
- Болезни инфекционной этиологии.
- Состояние инфаркта.
- Раковые образования.
- Заболевания, связанные с нарушением метаболизма, например, сахарный диабет.
Повышение нейтрофилов в крови называется нейтрофилией. Снижение этих клеток имеет название — нейтропения. Последнее состояние может возникать по причине радио- или химиотерапии, от приема антибиотиков или противовирусных средств.
Если в крови снижается уровень этих клеток, то среди возможных заболеваний могут быть такие инфекции, как грипп, оспа ветряная, тиф, краснуха, бруцеллез.
Также такая расшифровка может свидетельствовать о повышенной выработке гормонов щитовидки, а также о некоторых болезнях кровеносной системы (лейкоз в острой форме, апластическая анемия).
Лимфоциты
Лимфоциты являются ключевым элементом иммунной системы человека
Основными причинами лимфоцитоза, то есть высокого уровня лимфоцитов, являются:
Повышаются лимфоциты после отравления мышьяком, свинцом, тетрахлорэтаном и как побочные реакции на некоторые виды медикаментозных средств.
Возможными болезнями при обнаруженном снижении лимфоцитов считаются:
Низкий уровень лимфоцитов может быть после химиотерапии, приема глюкокортикостероидов.
Базофилы
Эти клетки в основном повышаются в результате таких патологических состояний:
- Аллергическая реакция на лекарства или пищевые продукты
- Ветряная оспа
- Миелолейкоз
- Нефроз
- Язвенный колит
- Гипотиреоз
- Гемолитическая анемия
Моноциты
Эти клетки могут повыситься вследствие заболеваний, которые спровоцированные грибками, паразитами, вирусами и патогенными бактериями. Некоторые специфицеские болезни также являются причинами повышения моноцитов в крови. На это также влияют ревматические болезни и патологии кроветворной системы. Высокий уровень моноцитов может быть в период восстановления после острого воспаления.
Низкий показатель моноцитов может свидетельствовать о гнойных поражениях, апластической анемии, волосатоклеточном лейкозе. Снижаются эти клетки также после родовой деятельности, в послеоперационный период, после применения таких стероидов, как преднизолон и дексаметазон.
Гематокрит
Если гематокрит ниже нормы, то это может свидетельствовать о почечной недостаточности, а также анемии. Понижаться показатель может и в случае беременности (в основном в последнем триместре).
Причинами повышенного гематокрита являются такие патологии:
- Сердечные болезни
- Эритремия
- Дыхательная недостаточность
- Обезвоживание организма
Тромбоциты
Тромбоциты – это самые мелкие клетки, которые участвуют в процессе свертывания крови
Тромбоцитопения – состояние, когда тромбоциты ниже нормы. Такое возможно при врожденной гемофилии, недоношенности.
К другим причинам пониженного уровня тромбоцитов относятся:
- Тромбоцитопеническая пурпура
- Красная волчанка
- Инфекционные болезни
- ДВС- синдром
- Тромбоз вен почек
- Сердечные патологии
- Ночная пароксизмальная гемоглобинурия
Высокий показатель клеток может свидетельствовать об таких патологических состояниях:
- Анемия (гемолитическая или железодефицитная)
- Раковые новообразования
- Переутомление вследствие большого физического перенапряжения
- Ревматизм в острой стадии
- Туберкулез
- Остеомиелит
- Абсцессы
- Повышаются тромбоциты также после оперативных вмешательств, а особо часто – при удалении селезенки
Повышение СОЭ происходит в случае физиологии, например, при беременности, а также в предменструальный период. Частой причиной высокого уровня СОЭ бывают онкозаболевания и опухолевые процессы. Возможными болезнями при высокой СОЭ считаются:
- Заболевания верхних и нижних отделов дыхательных путей.
- Отоларингологические болезни.
- Инфекции мочеполовой системы.
- Нарушения сердечно-сосудистой деятельности.
- Воспаления органов таза.
- Патологические состояния пищеварительных органов.
- Вирусный гепатит.
- Грибковая инфекция.
- Ревматологические заболевания.
- Почечная недостаточность.
Снижение скорости оседания происходит в результате приема медикаментозных препаратов, например, НПП, салицилаты, гормональные средства, иммунодепрессанты.
Заметили ошибку? Выделите ее и нажмите Ctrl+Enter, чтобы сообщить нам.
Добавить комментарий Отменить ответ
В продолжение статьи
Мы в соц. сетях
Комментарии
- ГРАНТ – 25.09.2017
- Татьяна – 25.09.2017
- Илона – 24.09.2017
- Лара – 22.09.2017
- Татьяна – 22.09.2017
- Мила – 21.09.2017
Темы вопросов
Анализы
УЗИ / МРТ
Новые вопросы и ответы
Copyright © 2017 · diagnozlab.com | Все права защищены. г. Москва, ул. Трофимова, д. 33 | Контакты | Карта сайта
Содержание данной страницы исключительно ознакомительного и информационного характера и не может и не являет собой публичную оферту, которая определяется ст. №437 ГК РФ. Предоставленная информация существует с ознакомительной целью и не заменяет обследование и консультацию у врача. Имеются противопоказания и возможны побочные эффекты, проконсультируйтесь с профильным специалистом
Источник: https://diagnozlab.com/analysis/clinical-tests/blood/obshhij-analiz-krovi-chto-vhodit.html
Какие показатели входят в общий (клинический) анализ крови
Каждый из нас хотя бы раз в жизни при малейшем подозрении на какое-либо заболевание сдавал ОАК – общий анализ крови.
Данное исследование самое:
- доступное, оно проводится в каждом государственном и частном ЛПУ, и по цене, приемлемой для любого кошелька,
- выполняется в кратчайшие сроки — сутки, а если стоит отметка CITO! – срочно – в течение 1,5 – 2 часов,
- информативное.
Может выполняться в виде:
- Тройки: Hb – гемоглобин, Le – лейкоциты, СОЭ – скорость оседания эритроцитов.
- Развернутого анализа с лейкоцитарной формулой.
Развернутый общий анализ крови включает в себя:
- Гемоголобин.
- Эритроциты.
- Цветовой показатель.
- Ретикулоциты.
- Тромбоциты.
- Лейкоциты: палочкоядерные, сегментоядерные, эозинофилы, базофилы, лимфоциты, моноциты.
- СОЭ.
Мы делаем общий анализ крови, что является обязательным при любом заболевании, для получения полноты картины состояния организма. Он входит в обязательный перечень обследования при профилактическом осмотре или обращении в ЛПУ по поводу, какого-либо недомогания. В него входят, прежде всего, показатели значений форменных элементов.
Войдите в интернет, и на запрос что входит в общий анализ крови, получите много разнообразной информации. Прочитав же эту статью, вы будете иметь полное представление об этом вопросе.
Но сначала стоит сказать, что кровь – это, прежде всего орган, который живет по своим физиологическим законам. Её объем составляет 6-7% массы взрослого человека. Она циркулирует по сосудам: артерии несут в себе кровь, обогащенную кислородом от легких ко всем органам и системам.
Это артериальная кровь, она алого цвета. А по венам течет кровь, насыщенная углекислым газом и продуктами обмена, это – венозная кровь темно-красного цвета. Проходя через печень, она очищается от ядов и токсинов. Снова поступает в легкие, обогащается кислородом и несет его вместе с питательными веществами в пункты назначения. И так происходит постоянно, бодрствуем ли мы или спим.
Кровь состоит из жидкой части – плазмы и форменных элементов.
В плазме растворены белки, минералы, витамины и продукты распада. Уменьшение её объёма приводит к сгущению крови и затруднению кровообращения, что может послужить причиной ишемических явлений – инфарктов и инсультов.
Форменные элементы также важная составляющая. Каждая, входящая туда группа, выполняет свои специфические функции. Их суммарное значение можно выразить в трех словах: транспорт, защита и регуляция.
Показатели крови
Клинический анализ крови включает исследование 5 основных параметров:
Их уровень указывает, какие изменения происходят в организме – здоров ли он или на лицо какой-то патологический процесс.
Остановимся подробнее на каждом из параметров.
Гемоглобин
Это белковое соединений с железом. Выполняет транспортную роль. Железо поступает в организм с пищей, его потребление в сутки должно быть не менее 20мгр. Оно лучше усваивается в присутствии витамина «С» и в больших количествах содержится в:
- красном мясе,
- свиной и говяжьей печени,
- гречке,
- кураге,
- орехах,
- черном изюме,
- гранате,
- абрикосах.
Его нормальные цифры говорят о хорошей кроветворной функции костного мозга. Снижение происходит при:
- Массивных внутренних и наружных кровотечениях.
- Хронических внутренних кровотечениях при миомах матки, язве желудка, двенадцатиперстной кишки, эрозивно-язвенных колитах.
- Нарушениях кроветворной функции.
Эритроциты
Кровяные тельца двояковогнутой формы, красный цвет получают за счет содержания гемоглобина. Играют транспортную и питательную роль. Их оценивают по форме, интенсивности окраски, количеству. Среди них не должно быть в норме больше 1% ретикулоцитов – молодых форм.
Повышение количества эритроцитов приводит к сгущению крови – эритроцитозу, которое может наблюдаться в жаркое время при обезвоживании организма, употреблении мочегонных препаратов длительное время, потере плазме. Снижение же количества эритроцитов говорит об анемии.
Тромбоциты
Бесцветные клетки выполняют одну из важнейших функций: остановка кровотечения, а также питание и восстановление целостности поврежденной стенки сосудов. За счет особого строения, у них имеются специальные отростки, они образуют в месте кровотечения сетку, на которую осаждается фибрин. Крепко связываются между собой и, таким образом, формируется пробка – тромб, закрывающий дефект стенки сосуда и кровотечение прекращается.
В случае повышения нормального уровня тромбоцитов наблюдается тромбоцитоз. Он приводит к повышенной свертываемости крови, которая предотвращает массивную кровопотерю во время операций. Но является патологической в нормальных условиях, так как приводит к повышенному тромбообразованию и к сосудистым катастрофам.
Лейкоциты
Белые кровяные тельца отвечают за защитные силы организма. Их повышенное количество говорит о:
- воспалительном процессе,
- инфекционном,
- отравлении,
- травме,
- каком-либо заболевании внутренних органов,
- либо лейкозе.
а пониженное – о проблемах в иммунном статусе. В клинический развернутый анализ крови всегда входит описание лейкоцитарной формулы:
- Эозинофилов.
- Лимфоцитов.
- Базофилов.
- Моноцитов.
- Палочкоядерных и сегментоядерных клеток.
Эозинофилы
Клетки-чистильщики, очищают организм от паразитов, ядов, токсинов. В норме их содержание 0,5-5%. Повышенное количество говорит о наличии различных паразитов, отравлении ядами и токсинами, а также и об аллергизации организма.
Лимфоциты
В норме количество колеблется в пределах 19-38%. Они отвечают за формирование иммунного ответа на клеточном и гуморальном уровнях. Так при вторжении чужеродных агентов они вызывают выработку специальных гормонов, которые в свою очередь стимулируют увеличение количества отряда Т-лимфоцитов. Именно они окружают «врага» и «уничтожают» его. Наглядный пример тому – образование фурункулов или абсцессов на месте внедрения инфекции, например стафилококка или стрептококка.
Базофилы
В норме их количество не должно превышать 1%. Они моментально реагируют на внедрение различных ядов, токсинов и при воспалительных процессах. Их уровень также повышается при некоторых заболеваниях крови, например миелолейкозе или гемолитической анемии.
Моноциты
Их нормальный уровень в крови находится в пределах 3-11%. Они осуществляют своеобразный face-контроль всех чужеродных веществ и дают команду на их уничтожение эозинофилам и лимфоцитам.
Иногда при описании лейкоцитарной формулы пишут «сдвиг влево или вправо». Сдвиг влево говорит о возрастании незрелых юных форм лейкоцитов в крови. Такую картину можно наблюдать при сепсисе, генерализованных инфекционных процессах, когда организм бросает все силы на борьбу с патологическим процессом. Он усиленно вырабатывает лейкоциты и тогда в кровь поступают незрелые элементы. А вот сдвиг вправо – характерен для заболевания печени и почек.
Цветовой показатель – соотношение объёма крови к эритроцитам. Он различный у мужчин, женщин и детей.
Ретикулоциты – это молодые эритроциты. Их показатель в норме колеблются в пределах 0,2-1,2%.
Скорость оседания эритроцитов говорит о том, с какой скоростью они склеиваются друг с другом. В норме показатели у женщин от 2-15мм/час, у мужчин – 1-10мм/час. Их повышение происходит при больших физических нагрузках, онкологических и воспалительных процессах.
Его высокие показатели при низких значениях лейкоцитов говорит о резком снижении иммунитета.
Из всего сказанного ясно, что кровь – это живой и важный орган человеческого организма. Каждая ее капля несет в себе жизнь!
Общий анализ крови
Под общим анализом крови врачи подразумевают исследование и оценку соответствующего материала на содержание ряда элементов — эритроцитов, гемоглобина, тромбоцитов, лейкоцитов.
Для чего нужен?
Общий клинический анализ крови — классическое врачебное исследовательское действие, при помощи которого можно выявить ряд несоответствий нормам концентраций отдельных веществ, которые свидетельствуют о наличии у человека ряда болезней и патогенных состояний.
С его помощью квалифицированный специалист может выявить у пациента разнообразные анемии и воспалительные процессы.
Показания к назначению
Общий анализ крови — обязательный пункт абсолютно любого комплексного осмотра. Его назначают всем группам категорий людей, особенно если есть подозрения на анемию любого рода либо же воспалительные заболевания. Кроме этого, клинический анализ крови является индикатором успешности лечения и «монитором» изменения состояния здоровья пациента.
Как сдавать?
Данный анализ сдаётся утром. В течение двенадцати часов до забора крови, желательно полностью воздержаться от приёма любой пищи и жидкостей, кроме обычной чистой воды. Сам анализ проводится в течения одного дня.
Чаще всего, забор крови осуществляется с безымянного пальца правой руки: его кончик сначала протирают спиртом, потом делают прокол и собирают специальной пипеткой в сосуд. Гораздо реже, кровь на общий анализ собирают из вены.
Процесс анализа и интерпретации результатов довольно оперативен, производится с помощью микроскопического исследования либо при помощи автоматизированной аналитической системы с подсчётом количества кровяных клеток, определением уровня гемоглобина и скорости оседания эритроцитов.
Норма показателей, исследование и расшифровка
Большинство полученных показателей общего анализа крови, можно интерпретировать самостоятельно.
RBC — эритроциты
Нормальный уровень для мужчин — от 4,3 до 6,2 * 10^12, для женщин и детей — от 3,6 до 5,5 * 10^12. Высокий уровень данных компонентов значительно увеличивает риск тромбоза. Низкий — анемия, кровопотеря, гидремия.
Референсные (нормальные) значения уровня эритроцитов представлены в таблице
GHB — гемоглобин
Норма для особого белка, содержащегося в эритроцитах — от 120 до 145 грамм на литр крови. Высокий их уровень свидетельствует о повышении уровня эритроцитом, низкий же приводит к системному кислородному голоданию организма.
Референсные (нормальные) значения уровня уровня гемоглобина представлены в таблице
HCT — гематокрит
Данный показатель обозначает объём эритроцитов, которые те занимают в жидкости. Норма выражается в процентном отношении — от 40-ка до пятидесяти у мужчин и от 35-ти до 45-ти у женщин. Снижение этого показателя свидетельствует об анемии, повышение диагностируется при обезвоживании и эритроцитозах.
Референсные (нормальные) значения гематокрита представлены в таблице
RDWC — ширина распределения RBC
Данный индикатор указывает на среднюю разницу в размерах эритроцитов, присутствующих в исследуемой крови. Норма для людей — 11–15 процентов. Показатели сверх нормы свидетельствуют об железодефиците и анемии.
MCV — средний объём RBC
Абсолютный усреднённый показатель размера эритроцитов в норме — от восьми десятков до сотни фемтолитров. Малый показатель является индикатором анемии и дефицита железа, слишком большой же — указывает на дефицит в организме, фолиевой кислоты или витамина В12.
MCH — содержание GHB в RBC
Норма данного отношения — от 26 до 34 пикограммов. Показатель ниже свидетельствует о дефиците железа, высокий уровень — о нехватке фолиевой кислоты и витаминов серии B.
MCHC — концентрация GHB в RBC
Вышеозначенный нормальный показатель насыщения эритроцитов, гемоглобином — от тридцати до 370-ти грамм на литр. Выше нормы — не встречается. Ниже нормы указывает на талассемию и дефицит железа.
PLT — тромбоциты
Норма тромбоцитов в крови — от 180-ти до 320-ти * 10^9 элементов на литр жидкости. Низкий их уровень чаще всего свидетельствует об апластической анемии, циррозе печени, а также ряда врожденных и аутоиммунных заболеваний. Высокий уровень диагностируется при заболеваниях крови, в послеоперационный период.
WBC — лейкоциты
Главный защитный механизм иммунной системы в норме показывает концентрацию от четырёх до девяти * 10^9 элементов на литр исследуемой жидкости. Снижение данного уровня свидетельствует о заболеваниях крови и негативных последствиях приёма ряда лекарственных препаратов, высокий уровень показывает наличие в организме, бактериальной инфекции.
Референсные (нормальные) значения уровня лейкоцитов представлены в таблице
LYM — лимфоциты
Лимфоциты — главный «строительный материал» иммунной системы. Нома содержания их в крови — от 1,2 до трёх * на 10^9 л. При значительно увеличенной их концентрации в крови, обычно диагностируются инфекционные заболевания широкого спектра. Низкий уровень — почечная/иммунная недостаточность, СПИД, хронические болезни широкого спектра, а также негативное влияние на организм, кортикостероидов.
MID/MXD — смесь базофилов, моноцитов, незрелых клеток и эозинофилов
Данный комплекс элементов обычно является результатом вторичных исследований при диагностике после забора крови на общий анализ. Норма показателя для здорового человека — от 0,2 до 0,8 * 10^9 элементов на литр.
GRAN — гранулоциты
Гранулированные лейкоциты являются активаторами работы иммунной системы в процессе борьбы с воспалениями, инфекциями и аллергическими реакциями. Норма для человека — от 1,2 до 6,8 * 10^9 эл/л. Уровень GRAN повышается при воспалениях, снижается при красной волчанке и апластической анемии.
MON — моноциты
Этот элемент считается вариацией лейкоцитов в макрофаговом виде, т.е. активной их фазой, поглощающей погибшие клетки и бактерии. Норма для здорового человека — от 0,1 до 0,7 * 10^9 эл/л. Снижение уровня MON обусловлено тяжелыми операциями и приёмом кортикостероидов, повышение свидетельствует о развитии ревматоидного артрита, сифилиса, туберкулёза, мононуклеоза и иных болезней инфекционной природы.
ESR/СОЭ — скорость оседания RBC
Косвенный нормальный показатель поведенческого фактора белков в плазме — до десяти мм/ч для представителей сильного пола и до пятнадцати мм/ч для представительниц прекрасного пола. Снижение СОЭ указывает на эритроцитоз и заболевания крови, повышение скорости оседания эритроцитов — на активизацию воспалительных процессов.
Референсные (нормальные) значения скорости оседания эритроцитов представлены в таблице
Таблица с нормами
Полезное видео
Передача «Жить здорово!», посвящённая различным анализам
Доктор Комаровский о клиническом анализе крови
Вместо послесловия
Выше, были указаны классические общепринятые обозначения результатов общего анализа крови. Ряд лабораторий может варьировать их результаты, выражая качественные, количественные и концентрационные показатели элементов в иных формах (например, процентной), что связано с использованием иной методологии подсчёта, однако сама суть результатов остаётся прежней.
Обязательно регулярно сдавайте общий анализ крови и будьте в курсе текущего состояния вашего организма! Не болейте, а предупреждайте проблему заранее, используя классические методы анализа.
Вопрос-ответ
Что такое биохимический анализ крови? И зачем его делают?
Биохимический анализ крови — это метод лабораторного исследования крови, который позволяет оценить состояние практически всех внутренних органов и самого человека в целом. Данный анализ делают для того, чтобы выяснить ряд заболеваний почек, печени, сердца и эндокринной системы.
Источник: https://www.doctorfm.ru/methods-diagnosis/obshchiy-analiz-krovi
Общий анализ крови
Общий анализ крови – это лабораторное исследование, универсальный и эффективный способ диагностики. Этот анализ позволяет оценить параметры общего функционирования организма человека, так как при расшифровке результатов общего анализа крови учитывается множество факторов. Это позволяет составить достаточно целостную и полную картину физиологических особенностей человека.
Что входит в общий анализ крови?
При проведении исследования определяют следующие основные параметры, которые заносят в бланк общего анализа крови:
- Гемоглобин (HGB) – белок, который содержится в эритроцитах и обеспечивает доставку кислорода из легких в клетки организма. Это железосодержащий комплекс, нормальный уровень которого колеблется в зависимости от возраста, пола, этнической принадлежности, вредных привычек, заболеваний и т.п.
- Эритроциты (RBC) – красные кровяные клетки, элементы крови, которые переносят гемоглобин. Главной функцией эритроцитов является доставка кислорода из легких ко всем органам и тканям, а двуокиси углерода обратно в легкие. Содержание эритроцитов связано с уровнем гемоглобина.
- Цветовой показатель – показатель степени насыщенности эритроцитов гемоглобином.
- Ретикулоциты – молодая форма эритроцитов.
- Тромбоциты (PLT) – клетки, которые участвуют в процессе свертывания крови. Тромбоциты обеспечивают гемостаз, остановку кровотечения, заживление ран. Содержание тромбоцитов является важным показателем при заболеваниях головного мозга, так как в нем они образуются.
- СОЭ – скорость оседания эритроцитов. Параметр, который позволяет выявить наличие воспаления, острой инфекции или отравления.
- Лейкоциты (WBC) – белые кровяные клетки, основной функцией которых является противодействие чужеродным агентам (вирусам, бактериям и т.п.). Выделяют 5 типов лейкоцитов: нейтрофилы, лимфоциты, моноциты, эозинофилы и базофилы. Определение процентного содержания каждого из них позволяет уточнить диагноз.
- Средний объем гемоглобина (MCH) – показатель, определяющий среднее количество гемоглобина в отдельных эритроцитах.
- Гематокрит (HCT) – показывает в процентах объемное содержание эритроцитов в объеме пробы крови.
- Ширина распределения эритроцитов в процентах (RDW) – показатель, определяющий различие эритроцитов по размерам.
Как подготовиться к анализу?
Общий анализ крови сдают утром натощак, так как в течение минимум 8 часов до отбора пробы нельзя принимать пищу и пить любые напитки, кроме простой воды.
Как расшифровать общий анализ крови?
Когда исследование будет завершено (обычно уже на следующий день), пациент получает бланк общего анализа крови, где указан перечень исследуемых параметров, их значение и нормы лаборатории, которая проводила тестирование. Так как нормы могут отличаться у различных лабораторий, именно от них зависит то, как расшифровать общий анализ крови.
Правильно интерпретировать результаты общего анализа крови может только врач. Тем не менее пациент может самостоятельно оценить значение основных параметров, сравнив их с нормативными. Так:
- Содержание эритроцитов ниже нормального уровня обычно является показателем анемии (малокровия), вызванной чаще всего дефицитом железа. Превышение красных кровяных телец (полицитемия) может быть вызвана нарушениями производства эритроцитов в костном мозге.
- Низкий уровень гемоглобина указывает на выраженную анемию, причинами которой может быть недостаток эритроцитов, острая или хроническая кровопотеря, недостаток витаминов В9 (фолиевая кислота) и В12, гемолиз, инфекции или наследственные заболевания системы кроветворения.
- Слишком низкое содержание тромбоцитов может свидетельствовать о кровотечении или вирусной инфекции. Высокий уровень тромбоцитов в некоторых случаях может стать причиной тромбообразования.
- Повышенное содержание лейкоцитов может указывать на наличие инфекционного или воспалительного процессов, аллергии, лейкоза, гемолиза. Тогда как низкий уровень лейкоцитов чаще всего сопровождает патологии костного мозга, различные инфекции, генетические аномалии иммунитета, повышение функции селезенки.
Общий анализ крови: подготовка и здача общего анализа крови
Как правильно сдавать анализ крови
В основу диагностики ложится ряд исследований, совокупность расшифровок которых являются показателями текущего состояния здоровья пациента. Одно из основных обследований по выявлению отклонений от норм — это общий анализ крови. Данные общего анализа крови по количественному содержанию нормальных веществ, и есть те самые решающие факторы, определяющие ход лечения и прогнозирования болезни.
Ни один врач не сможет установить диагноз, не сверившись с показателями общего анализа крови. Три четверти важной информации по состоянию здоровья выводится по результатам этого исследования.
Забор венозной крови
Забор венозной крови дает полную информативность относительно тех результатов, которые получают при общем анализе, взятом из пальца. Проведение данной процедуры необходимо при подозрении на заболевание любой этиологии. Этот метод обусловлен минимальной травматичностью, высокой скоростью проведения и, при соблюдении всех условий стерильности, является самым безопасным способом диагностики.
После прощупывания сосуда в локтевом сгибе, лаборант резиновым жгутом перетягивает руку в районе предплечья таким образом, чтобы остановить венозный кровоток. Затем происходит антисептическая обработка места проведения пункции, и введение иглы шприца в вену. Нужное количество крови определяется характером проводимого анализа.
В течение взятия крови из вены, необходимо прислушиваться к рекомендации лаборанта, последовательно выполняя его требования (сжатие, расслабления мышцы руки и др.). В ситуации резкого головокружения, тошноты, потемнения в глазах, нужно немедленно сообщить об этом медику.
Забор крови из пальца
Значительно отличается методика забора крови из пальца. Совершается прокол безымянного пальца специальной иглой-скарификатором, затем первая выступившая кровь стирается (она не несет необходимой информации) и происходит трехфазовый забор. Первично набранная кровь идет на выяснение уровня гемоглобина и СОЭ, вторая порция — на выявление количественного наличия форменных элементов. Третья фаза включает в себе приложение к месту прокола стерильного стеклышка, используемого затем, для изучения состава крови под микроскопом.
Как подготовиться к ОАК
Даже если методика выполнения забора анализа соответствовала всем основным требованиям, показатели крови могут быть искажены неправильным поведением самого пациента и игнорированием им подготовки, предшествующей анализу.
Существует набор определенных несложных правил, обуславливающих точность, соответствующую реальному состоянию человека:
- Исследование должно проводится натощак. Кушать перед ним нельзя на протяжении десяти часов минимум. Важно! Результаты анализа не могут считаться достоверными, если забор происходил во время продолжительных жестких ограничений в пище, строгих диет, резкой смены пищевых приоритетов (переход на вегетарианство, сыроедство);
- За день до обследования нельзя употреблять жирную пищу, а также перегружать почки и печень обилием белков. Последняя еда перед тем, как сдавать анализ, должна состоять преимущественно из постного мяса, круп, овощей. Пить чай, кофе, алкогольную продукцию, соки после последнего приема пищи не нужно. Воду пить можно в любом количестве;
- Исключить серьезные физические усилия непосредственно заминут до сдачи крови;
- Также, категорически запрещено курить в этот временной промежуток;
- Если в данный период пациент употребляет антибиотики, препараты, без которых не может обойтись, лаборант, принимающий анализ, должен об этом знать и сделать соответствующую пометку. Различные БАДы, витамины, лекарства второстепенного значения, перед сдачей крови принимать не нужно;
- На точность результатов серьезно влияет рентгенологическое излучение. Нужно соотнести эти два исследования таким образом, чтобы сдача анализов произошла не ранее, чем спустя сутки после рентгена.
Самыми и важными показателями, по результатам ОАК считаются: значения по количеству гемоглобина, эритроцитов, ретикулоцитов, эозинофилов, базофилов, гемокрита, гемостаза, тромбоцитов; показатели цвета, СОЭ.
Чтобы выявить возможные отклонения, требуется сверить полученную расшифровку с показаниями таблиц нормального соответствия. Такие таблицы существуют отдельно для взрослых людей, детей грудничкового и более старшего возраста, женщин в период беременности.
Для понимания параметров, указанных на бланке расшифровки, мало их прочитать — необходимо точно знать, что из себя представляет каждый из них. Ниже представлены самые важные значения.
Гемоглобин
Гемоглобин — это главный элемент в составе эритроцитов (красных кровяных телец). Понижение данного показателя характеризует первичные проявления анемии, развивающейся вследствие дефицита железа в организме. Напротив, повышение значения, может сигнализировать о развитии таких заболеваний, как:
Лейкоциты
Лейкоциты — это клетки, отвечающие за иммунную защиту организма. Повышение их обосновано ответной реакцией на проникновение в организм инородных тел, токсинов, вирусов, причем раздражители могут как появиться извне, так и образоваться в результате внутреннего воспалительного процесса.
Эритроциты
Эритроциты — это форменные элементы крови, имеющие в составе одинаковое количество гемоглобина. Эритроциты являются природными капсулами-транспортировщиками кислорода и углекислого газа по кровяному руслу сосудов.
Показания выше нормы количественных данных, может произойти в ответ на:
- гипоксию;
- различные хронические заболевания (в том числе, лейкоз, хронические бронхиты).
Понижение данных обусловлено:
- проявлениями анемии;
- воспалениями крови;
- дефицитом витамина В12;
- сильными кровотечениями.
Тромбоциты
Тромбоциты отвечают за поддержание жизнедеятельности гемостаза. Повышение их уровня возможно по причинам:
- кровотечения;
- чрезмерном физическом усилии;
- недостатке железа;
- туберкулезных заболеваниях;
- циррозных поражениях печени;
- ревматоидном артрите.
- заболеваниями аутоиммунного аппарата;
- усиленным разрушением тромбоцитов;
- ДВС-синдромом.
Лейкоциты
Лейкоциты, это белый кровяные вещества, создающие в организме иммунный барьер от воздействия посторонней микробиологической среды. Завышенные значения лейкоцитов говорят о следующих факторах:
- аллергической реакции;
- заболевании лейкозом;
- вирусном, инфекционном заболевании (грипп).
Показатели заниженные, сигнализируют о присутствии:
- вирусных инфекций;
- патологии иммунного аппарата генетического происхождения.
Для чего нужен общий анализ крови
Общий анализ крови, известный под аббревиатурой ОАК, является первым клиническим обследованием, назначаемым врачом при жалобе пациента на плохое самочувствие. Большинство заболеваний первично диагностируются, ориентируясь на ОАК, как на достаточное обоснования для лечебных назначений. Доступность этого исследования позволяет получить результат в течении нескольких часов, не придерживаясь никакой очередности.
Общий анализ крови (без лейкоцитарной формулы и СОЭ)
Общий анализ крови – набор тестов, направленных на определение количества различных клеток крови, их параметров (размера и др.) и показателей, отражающих их соотношение и функционирование.
ОАК, клинический анализ крови.
Complete blood count, CBC.
SLS(натрий лаурил сульфат)-метод.
*10^9/л (10 в ст. 9/л), *10^12/л (10 в ст. 12/л), г/л (грамм на литр), % (процент), фл (фемтолитр), пг (пикограмм).
Какой биоматериал можно использовать для исследования?
Венозную, капиллярную кровь.
Как правильно подготовиться к исследованию?
- Исключить из рациона алкоголь и лекарственные препараты (по согласованию с врачом) за сутки до сдачи крови.
- Не принимать пищу в течение 8 часов перед исследованием, можно пить чистую негазированную воду.
- Исключить физическое и эмоциональное перенапряжение и не курить в течение 30 минут до исследования.
Общая информация об исследовании
Общий анализ крови, как правило, включает в себя от 8 до 30 пунктов: подсчет количества эритроцитов, лейкоцитов, тромбоцитов в 1 микролитре или литре крови, а также ряд других показателей, описывающих форму, объем и другие характеристики этих клеток.
Обычно в дополнение к этим показателям общего анализа крови назначается лейкоцитарная формула (процентное соотношение различных форм лейкоцитов) и подсчет скорости оседания эритроцитов (СОЭ). Такое расширенное исследование чаще называют клиническим анализом крови.
Основные показатели, которые входят в таблицу результатов общего анализа крови:
- количество лейкоцитов (white blood cells, WBC),
- количество эритроцитов (red blood cells, RBC),
- уровень гемоглобина (hemoglobin content, Hb),
- гематокрит (hematocrit, Hct),
- средний объем эритроцита (MCV),
- среднее содержание гемоглобина в эритроците (MCH),
- средняя концентрация гемоглобина в эритроцитах (MCHC),
- тромбоциты (platelet count, PC).
Кровь состоит из клеток (форменных элементов) и жидкой части – плазмы. Эти клетки – эритроциты, лейкоциты и тромбоциты – образуются и созревают в костном мозге и должны попадать в системный кровоток по мере необходимости.
При изучении мазка крови под микроскопом капля крови помещается на стекло, размазывается шпателем, а затем окрашивается специальным красителем и высушивается. После этого врач лаборатории может детально рассмотреть ее под микроскопом.
Расшифровка общего анализа крови предполагает подсчёт форменных элементов и расчёт некоторых косвенных показателей. Так, отношение объема форменных элементов к плазме называется гематокритом. Изменение этого показателя характеризует степень «разжижения» или «сгущения» крови.
Лейкоциты – клетки, помогающие организму бороться с инфекцией. Они способны определять чужеродные агенты (бактерии, вирусы) в организме и уничтожать их.
Выделяют 5 различных видов лейкоцитов: эозинофилы, базофилы, нейтрофилы, лимфоциты и моноциты. Подсчет количества лейкоцитов, входящий в общий анализ крови, позволяет узнать суммарное количество всех типов клеток, лейкоцитарная формула, определяемая при клиническом анализе крови, – каждого типа в отдельности.
Общее количество лейкоцитов, как правило, повышено при остром инфекционном процессе, вызванном бактериями. Если лейкоцитов слишком мало, то организм становится более подверженным различным инфекциям.
Эритроциты – клетки, имеющие форму бублика с более тонкой частью в центре вместо дырки. В их составе есть гемоглобин – белок, содержащий железо, который обладает способностью переносить кислород от легких к тканям и органам, а углекислый газ – от тканей и органов к легким, из которых он выдыхается. Общий анализ крови позволяет определить, достаточное ли количество эритроцитов содержится в крови, какова их форма, размеры и содержание в них гемоглобина (MCV, MCH, MCHC). В норме, эритроциты должны быть одинаковы, однако при таких состояниях, как B12- или железодефицитная анемия, форма эритроцитов и их размер могут изменяться. Если количество эритроцитов, выявляемое общим анализом крови, снижено, значит, у пациента анемия, что может проявляться слабостью, быстрой утомляемостью и одышкой. Реже встречается повышение общего количества эритроцитов (эритроцитоз, или полицитемия).
Тромбоциты – клетки, играющие значительную роль в свертывании крови. Если у человека снижено количество тромбоцитов, риск кровотечения и образования синяков у него повышен.
Для чего используется исследование?
Данный тест применяют для общей оценки состояния здоровья, диагностики анемии, инфекций и множества других заболеваний. Фактически это совокупность анализов, оценивающих различные показатели крови.
- Подсчет количества лейкоцитов определяет количество лейкоцитов в единице крови (литре или микролитре). Его повышение или понижение может иметь значение в диагностике инфекций или, например, заболеваний костного мозга.
- Соответственно, количество эритроцитов в единице крови (литре или микролитре) определяет подсчет количества эритроцитов. Он необходим для диагностики анемии или полицитемии и дифференциальной диагностики различных типов анемий.
- Уровень гемоглобина важен для оценки тяжести анемии или полицитемии и для контроля за эффективностью терапии этих состояний.
- Гематокрит – процентное соотношение клеток крови (форменных элементов) к жидкой ее части. Используется в комплексной оценке анемий и полицитемий, для принятия решения о переливании крови и оценки результатов этой процедуры.
- Подсчет количества тромбоцитов определяет количество тромбоцитов в единице крови (литре или микролитре). Используется для выявления нарушений свертывания или заболеваний костного мозга.
- Средний объем эритроцита (MCV) – усредненный показатель, отражающий размер эритроцитов. Он необходим для дифференциальной диагностики различных типов анемий. Так, при B12-дефицитной анемии размер эритроцитов увеличивается, при железодефицитной – уменьшается.
- Среднее содержание гемоглобина в эритроците (MCH) – показатель того, сколько гемоглобина в среднем содержится в одном эритроците. При B12-дефицитной анемии в увеличенных эритроцитах количество гемоглобина повышено, а при железодефицитной анемии – снижено.
- Средняя концентрация гемоглобина в эритроците (MCHC) отражает насыщение эритроцита гемоглобином. Это более чувствительный параметр для определения нарушений образования гемоглобина, чем MCH, так как он не зависит от среднего объема эритроцита.
- Распределение эритроцитов по объему (RDW) – показатель, определяющий степень различия эритроцитов по размеру. Имеет значение в диагностике анемий.
- Средний объем тромбоцита (MPV) – характеристика тромбоцитов, которая может косвенно свидетельствовать об их повышенной активности или о наличии чрезмерного количества молодых тромбоцитов.
Когда назначается исследование?
Общий клинический анализ крови – самый распространенный лабораторный анализ, используемый для оценки общего состояния здоровья. Он выполняется при плановых медицинских осмотрах, при подготовке к оперативному вмешательству, входит в медкомиссию при устройстве на работу.
Если человек жалуется на утомляемость, слабость или у него есть признаки инфекционного заболевания, воспаления, повышенная температура тела, то, как правило, назначается это исследование. Расшифровка общего анализа крови становится первым шагом в диагностике многих серьезных заболеваний.
Значительное повышение количества лейкоцитов обычно подтверждает воспаление. Снижение эритроцитов и гемоглобина говорит об анемии и требует дополнительных обследований для уточнения ее причины.
Множество различных патологических состояний могут приводить к изменениям количества основных клеточных популяций в крови. Общий клинический анализ крови назначается для контроля за эффективностью лечения анемии или инфекционного заболевания, а также для оценки негативного влияния на клетки крови некоторых лекарств.
Что означают результаты?
Референсные значения (расшифровка общего анализа крови: таблицы нормы):
Повышение показателя – при инфекции, воспалительных процессах, онкологических заболеваниях и заболеваниях костного мозга.
Понижение – из-за некоторых лекарств (например, метотрексата), при ряде аутоиммунных заболеваний, при тяжелых инфекциях, нарушении работы костного мозга.
RDW-SD (распределение эритроцитов по объему, стандартное отклонение):fL.
RDW-CV (распределение эритроцитов по объему, коэффициент вариации)
Снижение показателей отмечается при железо-, B12-дефицитной и других анемиях, острых и хронических кровотечениях.
Повышение – при истинной полицитемии, обезвоживании, кислородном голодании.
Средний объем эритроцита (MCV)
Среднее содержание гемоглобина в эритроците (MCH)
Повышение показателя отмечается при B12- и фолиеводефицитной анемии.
Снижение – при железодефицитной анемии и талассемии.
Средняя концентрация гемоглобина в эритроците (MCHC)
Понижение показателя отмечается при анемии.
Повышение – при наследственном сфероцитозе.
10 дней – 1 месяц
6 месяцев – 1 год
Понижение – при иммунной тромбоцитопенической пурпуре, онкологических заболеваниях костного мозга, сепсисе. Повышение показателя отмечается при истинной полицитемии, онкологических заболеваниях, туберкулезе, удалении селезенки.
Что может влиять на результат?
На различные показатели общего анализа крови могут оказывать влияние, соответственно, разные факторы: беременность, курение, прием некоторых лекарств, интенсивная физическая нагрузка.
- Лейкоцитарная формула
- Скорость оседания эритроцитов (СОЭ)
- Ретикулоциты
Кто назначает исследование?
Терапевт, хирург, инфекционист, гематолог, нефролог.
Общий анализ крови
Общий анализ крови включает в себя подсчет всех видов клеток крови (эритроцитов, лейкоцитов, тромбоцитов), определение их параметров (размеры клеток и др.), лейкоцитарную формулу, измерение уровня гемоглобина, определение соотношения клеточной массы к плазме (гематокрит).
Общий анализ крови — лабораторное исследование, которое включает в себя подсчет всех видов клеток крови (эритроцитов, лейкоцитов, тромбоцитов), определение их параметров (размеры клеток и др.), лейкоцитарную формулу, измерение уровня гемоглобина, определение соотношения клеточной массы к плазме (гематокрит).
Какие существуют показания к назначению общего анализа крови?
Общий анализ крови проводится при большинстве заболеваний и профилактических обследованиях.
Что обозначают показатели общего анализа крови?
- Гемоглобин (HGB) — переносит кислород из легких в органы и ткани организма. Низкий гемоглобин указывает на анемию (малокровие).
- Эритроциты (RBC, «красные клетки крови») — элементы крови, содержащие гемоглобин. Уменьшение количества эритроцитов говорит об анемии (малокровии).
- Цветовой показатель является показателем степени насыщения эритроцитов гемоглобином.
- Ретикулоциты — молодые формы эритроцитов.
- Тромбоциты (PLT) — участвуют в процессе свёртывания крови. Снижение числа тромбоцитов говорит о плохой свертываемости крови. Естественное снижение уровня тромбоцитов отмечается во время менструации и в период беременности, а повышение — после физической нагрузки.
- СОЭ — скорость оседания эритроцитов. Увеличение СОЭ указывает на воспаление, острую инфекцию или отравление.
- Лейкоциты (WBC, «белые клетки крови») — отвечают за обезвреживание и клеточный иммунитет от вирусов и бактерий. Увеличение числа лейкоцитов — признак воспалительного процесса.
- Палочкоядерные (п/я) нейтрофилы.
- Сегментоядерные (с/я) нейтрофилы.
- Эозинофилы (эозинофильные гранулоциты) — разновидность лейкоцитов. Увеличение содержания эозинофилов может свидетельствовать об аллергических заболеваниях, наличии глистов.
- Базофилы (базофильные гранулоциты) – разновидность лейкоцитов.
- Лимфоциты — клетки иммунной системы, разновидность лейкоцитов. Отвечают за приобретённый иммунитет.
- Моноциты — крупные одноядерные лейкоциты.
Какая нужна подготовка к исследованию?
Анализ сдается утром, натощак. Не допускается в течение 8 часов (желательно 12) до сдачи анализов прием пищи, в том числе, сок, чай, кофе, алкоголь. Можно пить простую воду.
Источник: https://www.medhelp-home.ru/analiz-krovi/kakie-pokazateli-vhodyat-v-obcshij-analiz-krovi.html
travelinthesky.ru
Какие показатели входят в общий анализ крови
Гемоглобин (Hgb, Hb)
Это основной компонент, входящий в состав эритроцитов. Играет очень важную роль в организме человека, так как участвует в транспорте кислорода ко всем органам и тканям.
Оглавление:
1. У мужчин –г/л
2. У женщин –г/л
- (1 день) г/л
- (1 месяц) –г/л
- (6 месяцев) –г/л
- (12 месяцев) –г/л
- (1 – 6 лет) –г/л
- (7 – 12 лет) –г/л
- (13 – 17 лет) –г/л
- (18 лет) –г/л
Патологическое снижение наблюдается при:
- Всех видах анемий
- Гипергидратации организма – резкое увеличение объёма циркулирующей крови за счёт увеличения количества плазмы на фоне неизменённого числа форменных элементов крови, то есть кровяных клеток
Патологическое повышение отмечается при:
- Эритремии первичной и вторичной
- Обезвоживании организма – потеря жидкости, заключается в уменьшении количества плазмы, в то время количество кровяных клеток не изменяется
- Интенсивном курении
Красные кровяные клетки, участвующие в переносе кислорода к органам и тканям, а также осуществляющие в организме процессы биологического окисления.
Нормальное содержание эритроцитов в крови:
1. У мужчин – 4,2-5,6 *1012 /л
2. У женщин – 3,8-5,1*1012 /л
Патологическое снижение эритроцитов наблюдается при:
- Всех видах анемий
- Кровотечениях
- Беременности
- Гипергидратации организма
- Ускоренном разрушении красных клеток крови
- Снижении скорости образования эритроцитов в красном костном мозге
Патологическое повышение эритроцитов выявляется при:
Цветовой показатель (ЦП)
Указывает степень насыщенности гемоглобином красных кровяных клеток (эритроцитов).
- 0,9 – 1,1 – нормальный цветовой показатель
- 0,8 – 1,05 – нормохромные эритроциты
- Менее 0,8 – встречается при гипохромной анемии
- Более 1,1 – при гиперхромной анемии
При различных заболеваниях, сопровождаемых уменьшением количества эритроцитов в крови, происходит одновременное уменьшение содержания гемоглобина. Но, для правильного определения цветового показателя не достаточно знать только количество эритроцитов, важен и их объём.
- Нехватке фолиевой кислоты в организме
- Недостатке витаминаВ12
- Раковых опухолях
Уменьшение ЦП встречается при:
- Железодефицитной анемии
- Анемии, возникшей в результате отравления свинцом
Представляют собой молодые эритроциты. В норме на 1000 эритроцитов приходится 0,2 – 1% ретикулоцитов.
- Массивного кровотечения
- Гемолиза (разрушения) эритроцитов
- Лечения железодефицитной, фолиево- и витамин В12 -дефицитных анемий
- Недостатке кислорода в организме
Количество ретикулоцитов уменьшается в следующих случаях:
- При всех видах анемий
- Лучевой болезни
- Образовании метастазов в костях
- Радиотерапии
- Лечении цитостатиками (Циклофосфан, Доксорубицин, Фторурацил и др.)
Кровяные пластинки, которые принимают участие в гемостазе (комплекс реакций, протекающих в организме с целью остановки кровотечения при травмировании сосудов).
- Анафилактическом шоке
- Тромбоцитопеническая пурпура
- Метастазы опухолей в костный мозг
- Массивные гемотрансфузии
- Синдром Фанкони
- Системная красная волчанка
- Тромбоцитопения, ассоциированная с вирусной или бактериальной инфекцией
Патологическое повышение тромбоцитов происходит в случаях:
- После массивного кровотечения
- После удаления селезёнки
- После хирургических вмешательств
- Рак внутренних органов
- Гиперадренализм
- Атрофия селезёнки
Белые кровяные клетки. Различают пять видов белых кровяных телец: нейтрофилы, эозинофилы, базофилы, лимфоциты и моноциты. Процентное соотношение данных видов лейкоцитов и составляет лейкоцитарную формулу. В свою очередь нейтрофилы подразделяются на: миелоциты, метамиелоциты, палочкоядерные и сегментоядерные.
- Стрессовых состояниях
- Беременности
- Сильной физической нагрузке
- Выраженных эмоциях
- Лечении кортикостероидами в больших дозах
- Лечении адреналином
Патологическое увеличение содержания лейкоцитов сопутствует следующим состояниям:
- Различные инфекционные заболевания
- Инфаркт
- Опухоли
- После хирургических вмешательств
- После обильного кровотечения
- Гемолиз
- Диабетическая кома
- После некроза тканей
- Приступы подагры
Патологическое снижение количества лейкоцитов бывают при:
- миелоциты 0
- метамиелоциты 0
- палочкоядерные 0,04 – 0,3* 109 /л
- сегментоядерные 2,0 – 5,5 * 109 /л
- Инфекции, вызванные бактериями, вирусами, грибами и др.
- Воспалительные процессы в организме
- Злокачественные опухоли
- Лечение некоторыми лекарственными препаратами (кортикостероиды, гепарина, сердечные гликозиды, ацетилхолин)
- Интоксикации организма
- Эмоциональная нагрузка, стрессовые ситуации и физическое перенапряжение
- Состояния после хирургических вмешательств
Понижение уровня нейтрофилов сопровождает:
- Различные инфекции бактериального происхождения (брюшной тиф, паратиф)
- Инфекции вирусного происхождения (грипп, ветрянка, корь, краснуха)
- Лекарственные отравления
- Тиреотоксикоз
- Приём противоопухолевых препаратов
- Все виды анемий
- Анафилактический шок
Эозинофилы 0,02 – 0,3* 109 /л.
Увеличение количества эозинофилов возможно в случаях:
- Различные паразитарные инвазии (глистные, протозойные)
- Аллергические заболевания (бронхиальная астма, пищевая аллергия, поллинозы, аллергический ринит, лекарственная аллергия и др.)
- Заболевания кроветворных органов
- Злокачественные новообразования
- Кожные заболевания
- Инфаркт миокарда
- Заболевания соединительной ткани, носящие воспалительный характер (ревматоидный артрит, дерматомиозит, узелковый периартериит)
Уменьшение количества эозинофилов:
- Стрессовые ситуации
- Начальные стадии острых инфекционных заболеваний (ОРВИ)
- После лечения кортикостероидами
- Тяжёлые гнойные инфекции
Базофилы 0 – 0,65* 109 /л
Патологическое увеличение количества базофилов:
- Аллергические заболевания
- Инфекционные заболевания (хронические синуситы, корь, краснуха)
- Хронический миелолейкоз
- Болезнь Ходжкина
- Язвенный колит
- Нефроз
- Гипотиреоз и лечение антитиреоидными препаратами
Повышение уровня лимфоцитов:
- Вирусные инфекционные заболевания (коклюш, токсоплазмоз, вирусный гепатит, герпес, ВИЧ-инфекция и др.)
- Некоторые хронические заболевания (сифилис, туберкулёз)
- Пароксизмальный кашель
- Лейкемии и злокачественные лимфомы
Моноциты 0,09 – 0,6* 109 /л
Повышение уровня моноцитов в крови:
- Аллергические заболевания
- Инфекционные заболевания (корь, краснуха, хронический синусит)
- Заболевания крови миелопролиферативного характера
- Гранулоцитарная лейкемия
- Отравления тяжёлыми металлами
СОЭ — это скорость, с которой красные частицы крови выделяются из плазмы и оседают на дно пробирки, расположенной в вертикальном положении. В норме у женщин СОЭ составляет от 2 до 15 мм/ч, а у мужчин от 2 до 10 мм/ч. СОЭ подвергается широкой вариации в зависимости от пола, возраста и состояния организма. Так, например:
- у новорожденных детей 0 – 2 мм/ч
- у детей от 1 до 6 лет 12 – 17 мм/ч
- у женщин до 60 лет ≈ 12 мм/ч
- у мужчин до 60 лет ≈ 8 мм/ч
- у беременных до 20 – 25 мм/ч
- у пожилых людей до 15 – 20 мм/ч
Нормальное физиологическое увеличение СОЭ происходит:
- У детей
- После приёма пищи
- Во время менструаций
- При беременности и в послеродовом периоде
Патологическое увеличение СОЭ можно обнаружить при:
- Инфекционных заболеваниях
- Воспалительных заболеваниях
- Сепсисе
- Оперативных вмешательствах
- Заболеваниях почек и печени
- Эндокринных нарушениях
- Анемиях
- Болезни Ходжкина
Патологическое уменьшение СОЭ встречается в следующих случаях:
- Аллергические заболевания
- Эпидемический гепатит
- Эритремия
- Хроническая недостаточность кровообращения
Читать еще:
Отзывы
Сдавали по причине атопического дерматита.
Очень сложно найти врача-специалиста хорошего!
Спасибо Вам за ваше участие и внимание.
Оставить отзыв
Вы можете добавить свои комментарии и отзывы к данной статье при условии соблюдения Правил обсуждения.
Источник: https://www.tiensmed.ru/news/obshcii-analiz-krovi1.html
Общий анализ образца крови: что в него включено
Кровь на общий анализ наиболее часто берут для диагностики заболеваний и контроля эффективности лечения. Образец крови для него забирают из пальца или вены. Его назначают практически всем, кто обратился за помощью к врачу. При правильной расшифровке данных можно получить сведения о присутствии паразитов, воспалительных процессах и определить наличие того или иного заболевания. Рассмотрим, что в себя включает общее лабораторное исследование образца крови.
Общий анализ: насколько показательно это исследование
Изменение состава крови может помочь диагностировать практически любое заболевание. На нарушения в работе внутренних органов быстрее всего реагирует именно кровь. Анализ стоит расшифровывать именно врачу, так как нормальные показатели изменяются, в зависимости от возраста, пола и состояния здоровья.
В ходе исследования проверяют:
- количество основных компонентов (эритроцитов, тромбоцитов, лейкоцитов);
- гематокрит и гемоглобин;
- СОЭ;
- лейкоцитарную формулу;
- цветовой показатель.
Врачу данные передаются в виде столбца цифр и условных обозначений, глядя на который он сможет понять, что происходит с вашим организмом. Далее он рассмотрит в комплексе симптомы и полученные результаты, чтобы поставить точный диагноз или понять, помогает ли лечение.
Общий анализ обычно назначается одновременно с другими исследованиями, например, рентгенографией или УЗИ. Отдельно кровь могут проверить на соотношение в ней гормонов, уровень сахара и антител к разным заболеваниям.
Особенности проведения анализа
Если вам предстоит сдать анализ крови, то не стоит накануне есть жареное и принимать алкоголь. Помните, что жирная пища способна изменить количество лейкоцитов. В этом случае врач может диагностировать у вас серьезное заболевание, которого нет на самом деле.
Утром не стоит пить воду, чистить зубы и даже есть. Несмотря на современные исследования, многие врачи считают, что сданный натощак анализ самый информативный. Он дает более четкую картину о состоянии здоровья.
Чтобы провести общий анализ, в процедурном кабинете у пациента берут несколько капель крови:
- для определения СОЭ;
- для исследования на уровень гемоглобина;
- для подсчета количества лейкоцитов и эритроцитов (делают мазки на стеклах).
Забор крови обычно приходится на утренние часы. Большинство лабораторий делают общий анализ в течение нескольких часов. Поэтому уже после обеда вы сможете узнать у своего лечащего врача результаты. Если специалист, выдавший направление на анализ, не принимает в послеобеденные часы, то на прием стоит записываться на следующий день.
Эритроциты и СОЭ
Как и любой показатель, количество эритроцитов может быть повышено и понижено, что является свидетельством разных состояний. Как правило, в результатах количество этого компонента указывается в единицах, умноженных на/л. Нормой считаются результаты:
- для грудных младенцев (до шести месяцев) – от 3,1 до 4,5;
- для детей от года и старше – от 3,4 до 5;
- для женщин – от 3,5 до 5;
- для мужчин – от 4 до 5,5.
Анализ крови может показать, что количество эритроцитов повышено в следующих случаях:
- при росте новообразований (дополнительно назначается проверка на онкомаркеры);
- при синдроме Кушинга;
- при заболеваниях подобных водянке почечных лоханок.
Прием стероидных препаратов может смазать картину и сделать анализ крови недостоверным, так как эти фармакологические средства увеличивают количество эритроцитов. Показатели ниже нормы бывают в случаях, когда эритроциты ускоренно разрушаются:
Анализ может быть недостоверным, если вы принимаете мочегонные средства, тогда количество эритроцитов будет снижено.
СОЭ (скорость выпадения эритроцитов в осадок) измеряется в мм/ч. Приняты следующие нормы:
- для мужчин – от 2 до 10;
- для женщин – от 3 до 15 (при беременности до 25);
- для новорожденных – до 2;
- для грудных детей – от 12 до 17.
Этот показатель может также изменяться в зависимости от состояния организма. После операций при воспалительных процессах и переломах СОЭ обычно увеличивается. Снижается оно при недостаточности кровообращения. СОЭ напрямую зависит от других компонентов крови, таких как гормоны и антитела. Если у женщины увеличивается СОЭ, то ей необходимо пройти обследование репродуктивной системы.
Гемоглобин и цветовой показатель
Средний показатель гемоглобина колеблется от 120 г/л и достигает 140. У новорожденных он обычно выше и достигает до 200 г/л. Если в клетки организма поступает мало кислорода, то уровень гемоглобина снижается. Повышает его:
Снижение гемоглобина нередко свидетельствует об анемии, связанной с дефицитом железа. Если одновременно с этим понижен цветовой показатель, то это способно подтвердить анемию или выявить нарушение выработки гемоглобина организмом. Цветовой показатель может быть повышен при образовании полипов в желудке, а также при дефиците витамина В12 и фолиевой кислоты.
Тромбоциты
Один из самых переменчивых показателей, который исследует анализ крови, – количество тромбоцитов. У взрослых в норме их должно быть от 180 до 320 единиц (умноженных на 10 9 /л). Это количество может колебаться из-за изменений погоды, стрессов, времени суток и приема лекарственных средств.
Влияет на количество тромбоцитов и гормональный фон, особенно у женщин. При этом анализ образца крови был бы неполным, если количество этого компонента не измерялось в ходе лабораторной проверки. Он важен для определения скрытых воспалительных процессов, аутоиммунных заболеваний, инфекциях и нарушениях функции щитовидной железы.
Лейкоциты
Бесцветные клетки крови исследуются более тщательно. Они бывают четырех видов. Анализ определяет соотношение каждой разновидности по специальной формуле. Нормой считается уровень лейкоцитов от 4 до 9 единиц, умноженных на 10 9 /л. У детей до года количество бесцветных клеток бывает выше.
Падение уровня лейкоцитов может быть свидетельством появления метастаз, лучевой болезни и повреждениях костного мозга. Увеличивается количество клеток при:
- сепсисе;
- присутствии в организме грибковых и вирусных заболеваний;
- инфекциях;
- воспалительных процессах;
- травмах;
- злокачественных опухолях.
Помните, что расшифровать анализ крови правильно может только врач. Он будет смотреть на показатели комплексно. Также при постановке диагноза специалисты опираются на симптоматику и данные других исследований.
Источник: https://serdcelechim.ru/diagnostika/obshhij-analiz-obrazca-krovi-chto-v-nego-vklyucheno.html
Перечень того, что входит в показатели общего анализа крови, особенности применения и клиническая значимость в диагностике заболеваний
Общеклинический анализ крови – важная часть диагностики пациентов, поступивших в муниципальные или частные поликлиники. Многие патологические состояния отражаются на составе крови. Общий анализ крови (ОАК) дает возможность оценить квантитативные и качественные показатели. Любые изменения свидетельствуют о нарушении в работе внутренних органов.
Что входит в общий анализ крови?
Многие задаются вопросом, что включает в себя общий анализ крови? Данное обследование оценивает количественное содержание красных и белых клеток, тромбоцитов. Анализ включает в себя и анализ качественных свойств крови – СОЭ, цветовой показатель, относительную ширину распределения тромбоцитов, лейкоцитарные индексы и другие.
Показатели крови в общем анализе крови позволяют на ранней стадии диагностировать анемию. Это патологическое состояние, характеризующееся снижением абсолютного содержания гемоглобина и эритроцитов.
В ОАК входит анализ трех типов клеток крови:
Красные тельца крови
Эритроциты – это безъядерные клетки, транспортирующие двуокись углерода и кислород в человеческом организме. Транспорт происходит с помощью четвертичной глобулы – гемоглобина. Он является тетрамером и состоит из четырех субъединиц: альфа и бета 1-2.
Гемоглобин состоит из простетической группы и белковой части. Пептидную составляющую принято называть глобулой, а простетическую – гемом. Последний состоит из железа и придает крови характерную окраску. Гемоглобин, связываясь с кислородом и двуокисью углерода, может находиться в трех формах:
- Оксигемоглобин;
- Карбоксигемоглобин;
- Дезоксигемоглобин.
Поставкой кислорода в ткани занимается оксигемоглобин. Он образуется при высоком парциальном давлении в легких. Оксигемоглобин способен переносить до 4 молекул кислород одновременно. Выведением оксидов углерода (монооксидов/диоксидов) занимается карбоксигемоглобин. Несвязанным гемоглобином принято называть дезоксигемоглобином.
Оксигемоглобин окрашивает кровь в ярко-алый цвет, а дезоксигемоглобин – в синевато-красный. Этим объясняются различия в окраске крови. В артериальной крови содержится больше оксигемоглобина, а в венозной – дезоксигемоглобина.
При некоторых патологических состояниях (наследственных или приобретенных) отмечается резкое снижение общего числа эритроцитов и гемоглобина. Такое состояние, как упоминалось выше, принято называть анемией. Народное наименование этого расстройства – «малокровие». Анемия может возникнуть вследствие нехватки витаминов (В12), железа или в результате патологических состояний (например, идиопатической гипертрофии селезенки).
В ряде случаев изменяются не количественные, а качественные параметры – например, размер эритроцитов. Изменение ширины распределения красных клеток в медицине называют анизоцитозом. Такие состояния относительно редки, однако возникают из-за онкологии (рака крови) или недостатка витаминов группы В.
В клиническом анализе крови гемоглобин и эритроциты обозначаются латинскими буквами RBC и HGB. Нормальное значение красных клеток в русле крови варьируется в пределах от 4,0-6,0 миллионов на микролитр, а гемоглобина –грамм на литр.
Стоит отметить, что у женщин и детей уровень эритроцитов немного ниже нормы – 3,7-4,8 миллионов на микролитр. Вследствие этого у лиц женского пола риск развития анемии выше, чем у мужчин.
Белые кровяные тельца и клинический анализ крови: что входит в этот анализ?
Лейкоциты – это клетки кровеносного русла, обеспечивающие бесперебойную защиту организма от патогенных факторов внешней среды (бактериальных, вирусных, паразитарных и других инфекций). Они синтезируются в костном мозге и транспортируются в русло крови. Выделяют 3 типа белых клеток:
- Лимфоциты. Эти клетки синтезируют специальные пептидные соединения – иммуноглобулины. Они помогают в распознавании и обезвреживании микроорганизмов.
- Гранулоциты (эозинофилы, базофилы и нейтрофилы). Большая часть всех гранулоцитов – микрофаги. Свое название они получили из-за наличия в цитоплазме специфической грануляции. Микрофаги захватывают относительно мелкие частицы.
- Моноциты. Обеспечивают противораковый, антибактериальный и противопаразитарный иммунитет, синтезируя специальные вещества – цитотоксины (интерлейкин, интерферон и факторы некроза опухоли). Они являются макрофагами, поскольку захватывают относительно крупные чужеродные микроорганизмы или частицы.
Общая концентрация белых клеток крови возрастает при инфекционных, воспалительных, аллергических, вирусных и идиопатических причинах. Лейкоцитозом принято называть увеличение числа лейкоцитов выше нормы. Причиной этого явления может быть мононуклеоз, коклюш, пневмония, туберкулез, сифилис, гепатит, ВИЧ и другие болезни.
При некоторых патологических состояниях уровень данных клеток резко снижается. Такое состояние принято называть лейкопенией.
Причины возникновения лейкопении:
- Брюшной тиф;
- Анафилактический шок (последняя стадия аллергии);
- Коллагенозы;
- Лейкоз;
- Плазмоцитома;
- Болезнь Аддисона-Бирмера;
- Прием нестероидных противовоспалительных препаратов;
- Длительное лечение антибактериальными медикаментами;
- Патологии костного мозга;
- Злокачественные или доброкачественные новообразования.
В общетерапевтическом исследовании крови данный параметр принято обозначать латинским знаком L. Нормальные показатели лейкоцитов варьируются в зависимости от возрастной категории. Поэтому анализировать их нужно с учетом пола и возраста.
Нормой абсолютного количества лейкоцитов у взрослых людей принято считать 3-8 миллиард клеток на литр. В подсчет абсолютного числа белых клеток могут войти дополнительные методы диагностики – лейкоформулы. Они позволяют точнее увидеть течение (стадию) и выяснить этиологию болезни.
Лейкоцитарная формула – это соотношение различных типов белых клеток, выраженное в процентах. Сдвиги лейкограммы в определенные стороны должен насторожить лечащего врача. При сдвиге в левую сторону увеличивается числа палочкоядерных нейтрофилов (незрелых) и других клеток-предшественниц. При сдвиге в правую сторону – уменьшение общего числа лейкоцитарных гранулоцитов. Кроме лейкоформулы, выделяют и другие индексы, коэффициенты, которые применяются на начальных этапах диагностики заболеваний различной этиологии.
Пластинчатые клетки и клинический анализ крови: что входит в анализ данного показателя?
Тромбоциты – это безъядерные клетки, которые образуются в результате дифференцировки мегакариоцитов. Синтез тромбоцитов происходит в костном мозге. Пластинчатые клетки играют важную роль в свертывающей системе крови. Их главная функция – образование первичной пробки (бляшек, состоящих из холестерина, кальция, калия и других элементов), которая останавливает кровотечение.
На начальном этапе тромбоциты прикрепляются к компонентам субэндотелия – это называется адгезией. На второй стадии они меняют форму, активируют рецепторы и секретируют вещества-химические посредники. На третьем этапе они соединяются друг с другом через рецепторные мосты и формируют сгустки. Формирование этой пробки (первичного гемостаза) связано с активацией коагуляционного каскада с результирующим осаждением фибрина.
Снижение абсолютного числа пластинчатых клеток в кровеносном русле принято называть тромбоцитопенией. Такое состояние возникает при различных болезненных состояниях: идиопатической тромбоцитопенической пурпуре, болезни Гоше, анемии различной этиологии. Уменьшение числа данных клеток ведет к развитию тяжелых кровотечений, которые сложно остановить даже в медицинских условиях.
Увеличение числа тромбоцитов называют тромбоцитозом. Такое состояние ведет к тромбозам, которые перекрывают кровоток в различных частях тела (в зависимости от локализации) и приводят к сердечно-сосудистым катастрофам. Заболевания, которые вызывают тромбоцитоз:
- Гемолитический уремический синдром;
- HELLP-синдром;
- Лихорадка Денге;
- Миелопролиферативный синдром.
В полном развернутом анализе русла крови нормальными показателями тромбоцитов принято считатьмлрд клеток на литр. В подростковом возрасте данный показатель немного выше нормы. В исследовании крови данный показатель обозначается как PLT – platelets.
Биохимический общий анализ крови: что входит в него?
Биохимия крови – это обширный анализ, в котором оценивают работу внутренних органов и метаболизм различных соединений (сахаров, пептидов или животных липидов). В данном обследовании анализируют и содержание макро- и микроэлементов. Показанием для проведения данного диагностического мероприятия может быть жалоба пациента или превентивный осмотр.
Некоторых интересует ответ на вопрос, что включает общий биохимический анализ крови? В зависимости от целей диагностики зависит выбор показателей для исследования. Если имеется подозрение на сахарный диабет – врач назначит прохождение теста на уровень глюкозы. Иногда пациентам нужно сдавать мочу (для оценки показателей в условиях инвитро на наличие бактерий) вкупе с кровью, чтобы провести точную дифференциальную диагностику.
Если требуется проверить беременность – назначается анализ на наличие хорионического гонадотропина человека (ХГЧ). Высокая его концентрация указывает, что женщина находится в положении.
Нередко проверяют концентрацию печеночных и поджелудочных ферментов, азотистых соединений (мочевину или остаточный азот).
Как подготовиться к анализу?
Берут биоматериал из локтевого сгиба, где располагается вена. Однако при некоторых анализах забор крови производится из пальца. Перед сдачей материала не рекомендуется употреблять пищу (особенно сахара) за 12 часов. Следует исключить прием психотропных веществ (алкоголь, никотин или кофеин) за 48 часов и различных медикаментов. При несоблюдении перечисленных рекомендаций анализы могут показать ложноположительный результат.
Беременным женщинам рекомендуется избегать тяжелых физических нагрузок и психоэмоциональных перегрузок. От жидкости за 3 часа до обследования стоит также отказаться.
Совет! Расшифровка результатов, входящих в ОАК, производится исключительно квалифицированным специалистом. Не стоит заниматься самодиагностикой или самолечением. Не зная основ, можно сильно ошибиться и усугубить имеющееся состояние. При самостоятельном лечении врач не будет отвечать за действия больного.
Источник: https://lechiserdce.ru/analiz-krovi/10575-chto-vhodit-v-obshhego-analiza-krovi.html
Что входит в общий анализ крови: расшифровка основных показателей
Подготовка к анализу и проведение процедуры
Расшифровка: норма основных показателей
Количество эритроцитов
- Мужчины — от 4 до 5
- Женщины – от 3,5 до 4,7
- Мальчики – подростки – от 4,5 до 5,3
- Девочки – подростки – от 4,1 до 5,1
- Дети в возрасте от шести до двенадцати лет – от 4 до 5,2
- Дети с двухлетнего возраста – от 3,9 до 5,3
- С полугода до двух лет – от 3,7 до 5,3
- Малыши в два месяца – от 2,7 до 4,9
- Один месяц — от 3 до 5,4
- Первые дни жизни – от 4 до 6,6
Лейкоциты
- Эозинофилы – помогают очищать организм от паразитов, токсинов, борются с раковыми клетками.
- Нейтрофилы – бывают незрелыми или палочкоядерными, а также зрелыми (сегментоядернымы)
- Моноциты – являются иммунными клетками, распознают в организме чужеродные вещества.
- Базофилы – мелкие клетки, которые способствуют иммунологическим реакциям.
- Лимфоциты – формируют иммунный ответ гуморального и клеточного плана.
- Для взрослых – от 4 до 9 клеток в поле зрения
- С шести до шестнадцати лет – от 4,5 до 13,5
- От двух до шести лет – от 5 до 15,5
- У детей – грудничков нормальным считается показатель лейкоцитов от 6 до 17,5.
- Нормой нейтрофилов считаются показатели палочкоядерных (от одного до шести процентов) и сегментоядерных (от 47 до 72 %). Наиболее высокая концентрация нейтрофилов сегментноядерных в организме наблюдается у новорожденных и взрослых людей. Палочкоядерные могут колебаться от 3 до 12% в первые дни жизни ребенка.
- Уровень моноцитов в крови должен находиться в пределах от 3 до 11%.
- Базофилы в лейкоцитарной формуле не должны превышать 1%
- Эозинофилов в крови может быть от 0,5 % до 5%
- Для лимфоцитов нормой является показатель от 19 до 37%
Гематокрит
- До 45 лет – от 42 до 50%
- До 65 лет – от 39 до 50%
- Старше 65 лет – от 37 до 51%
- До 45 лет – от 38 до 47%
- До 65 лет и старше – от 35 до 47%
- Новорожденные – от 41 до 65%
- До трех месяцев – от 28 до 42%
- До полугода — от 31 до 41%
- До года – от 33 до 41 %
- До трёхлетнего возраста – от 32 до 40%
- К шести годам – от 32 до 42%
- До 12 лет – от 34 до 43%
- У девушек – подростков уровень гематокрита несколько ниже, чем у мальчиков.
Тромбоциты
- Женщины – до 20 мм за час
- Мужчины – до 15 мм
- Дети – от двух до десяти мм за один час
Основные причины отклонений от нормы, возможные заболевания
Эритроциты
- Эритремия
- Стеноз артерии почек
- Обезвоживание организма в результате диареи, рвоты, пониженного количества употребляемой суточной дозы жидкости
- Сердечная недостаточность
- Заболевания легких
Лейкоциты
- Чрезмерные физические нагрузки.
- Период после вакцинации.
- Первые часы после употребления пищи.
- Середина второго-третий триместр беременности.
- Дни менструации.
- Лейкоз
- Злокачественные новообразования
- Опухолевые процессы
- Обширные травмы
- Ожоги
Нейтрофилы
- Воспалительные процессы внутренних органов.
- Болезни инфекционной этиологии.
- Состояние инфаркта.
- Раковые образования.
- Заболевания, связанные с нарушением метаболизма, например, сахарный диабет.
Лимфоциты
Базофилы
- Аллергическая реакция на лекарства или пищевые продукты
- Ветряная оспа
- Миелолейкоз
- Нефроз
- Язвенный колит
- Гипотиреоз
- Гемолитическая анемия
Моноциты
Гематокрит
- Сердечные болезни
- Эритремия
- Дыхательная недостаточность
- Обезвоживание организма
Тромбоциты
- Тромбоцитопеническая пурпура
- Красная волчанка
- Инфекционные болезни
- ДВС- синдром
- Тромбоз вен почек
- Сердечные патологии
- Ночная пароксизмальная гемоглобинурия
- Анемия (гемолитическая или железодефицитная)
- Раковые новообразования
- Переутомление вследствие большого физического перенапряжения
- Ревматизм в острой стадии
- Туберкулез
- Остеомиелит
- Абсцессы
- Повышаются тромбоциты также после оперативных вмешательств, а особо часто – при удалении селезенки
- Заболевания верхних и нижних отделов дыхательных путей.
- Отоларингологические болезни.
- Инфекции мочеполовой системы.
- Нарушения сердечно-сосудистой деятельности.
- Воспаления органов таза.
- Патологические состояния пищеварительных органов.
- Вирусный гепатит.
- Грибковая инфекция.
- Ревматологические заболевания.
- Почечная недостаточность.
Добавить комментарий Отменить ответ
В продолжение статьи
Мы в соц. сетях
Комментарии
- ГРАНТ – 25.09.2017
- Татьяна – 25.09.2017
- Илона – 24.09.2017
- Лара – 22.09.2017
- Татьяна – 22.09.2017
- Мила – 21.09.2017
Темы вопросов
Анализы
УЗИ / МРТ
Новые вопросы и ответы
Общий анализ крови (ОАК): что показывает, норма и отклонения, таблицы результатов
Общий анализ крови относят к рутинным исследованиям любой клинической лаборатории – это первый анализ, который сдает человек, когда проходит диспансеризацию или когда заболеет. В лабораторном деле ОАК относят к обще-клиническим методам исследования (клинический анализ крови).
Даже люди, далекие от всех лабораторных премудростей, пестрящих массой трудновыговариваемых терминов, неплохо ориентировались в нормах, значениях, названиях и прочих параметрах до тех пор, пока в бланке ответа фигурировали клетки лейкоцитарного звена (лейкоцитарная формула), эритроциты и гемоглобин с цветным показателем. Повсеместное заселение медицинских учреждений всевозможным оборудованием не минуло и лабораторную службу, многие бывалые пациенты оказались в тупике: какая-та непонятная аббревиатура из латинских букв, много всяких чисел, различные характеристики эритроцитов и тромбоцитов…
Расшифровка собственными силами
Трудности для пациентов составляет общий анализ крови, произведенный автоматическим анализатором и скрупулезно переписанный в бланк ответственным лаборантом. Кстати, «золотой стандарт» клинических исследований (микроскоп и глаза врача) никто не отменял, поэтому любой анализ, производимый для диагностики, должен быть нанесен на стекло, прокрашен и просмотрел с целью выявления морфологических изменений клеток крови. Аппарат в случае значительного уменьшения или увеличения какой-то популяции клеток может не справиться и «запротестовать» (отказаться работать), как бы хорош он ни был.
Иногда люди пытаются найти различия между общим и клиническим анализом крови, однако искать их не нужно, потому что клинический анализ подразумевает то же самое исследование, которое для удобства называют общим (так короче и понятней), но суть от этого не меняется.
Общий (развернутый) анализ крови включает:
- Определение содержания клеточных элементов крови: эритроцитов — красных кровяных телец, содержащих пигмент гемоглобин, определяющий цвет крови, и лейкоцитов, которые этот пигмент не содержат, поэтому называются белыми клетками крови (нейтрофилы, эозинофилы, базофилы, лимфоциты, моноциты);
- Уровень гемоглобина;
- Гематокрит (в гематологическом анализаторе, хотя приблизительно можно определить и на глаз после того, как эритроциты спонтанно осядут на дно);
- Цветовой показатель, рассчитанный по формуле, если исследование проводилось вручную, без участия лабораторного оборудования;
- Скорость оседания эритроцитов (СОЭ), которую раньше называли реакцией (РОЭ).
Общий анализ крови показывает реакцию этой ценной биологической жидкости на любые процессы, происходящие в организме. Сколько в ней содержится красных клеток крови и гемоглобина, выполняющих функцию дыхания (перенос тканям кислорода и изъятие у них углекислого газа), лейкоцитов защищающих организм от инфекции, тромбоцитов, участвующих в процессе свертывания, как организм реагирует на патологические процессы, словом, ОАК отражает состояние самого организма в разные периоды жизни. Понятие «развернутый анализ крови» обозначает, что, помимо главных показателей (лейкоциты, гемоглобин, эритроциты), детально изучается лейкоцитарная формула (гранулоциты и клетки агранулоцитарного ряда).
Расшифровку анализа крови лучше доверить врачу, но если есть особое желание, то пациент может попробовать самостоятельно изучить выданный в клинической лаборатории результат, а мы ему в этом поможем, совместив привычные названия с аббревиатурой автоматического анализатора.
С таблицей проще разобраться
Как правило, результаты исследования заносятся в специальный бланк, который направляется врачу или выдается на руки пациенту. Чтобы было легче ориентироваться, попробуем представить развернутый анализ в виде таблицы, в которую внесем норму показателей крови. Читатель в таблице увидит еще и такие клетки, как ретикулоциты. Они не входят в число обязательных показателей общего анализа крови и представляют собой молодые формы красных кровяных телец, то есть, являются предшественниками эритроцитов. Ретикулоциты исследуют с целью выявления причины анемии. В периферической крови взрослого здорового человека их совсем немного (норма приведена в таблице), у новорожденных детей этих клеток может быть в 10 раз больше.
в абсолютных значениях, 10 9 /л
в абсолютных значениях,10 9 /л
И отдельная таблица для детей
Приспособление к новым условиям жизни всех систем организма новорожденных, дальнейшее их развитие у детей после года и окончательное формирование в подростковом возрасте делает показатели крови отличными от таковых у взрослых. Не стоит удивляться, что нормы маленького ребенка и человека, перешагнувшего совершеннолетний возраст, могут иной раз заметно разниться, поэтому для детей существует своя таблица нормальных значений.
первые дни жизни
первые дни жизни (за счет фетального Hb)
Следует отметить, что в разных медицинских источниках и в разных лабораториях могут отличаться и значения нормы. Это связано не с тем, что кто-то не знает, сколько должно быть тех или иных клеток или каков нормальный уровень гемоглобина. Просто, используя различные аналитические системы и методики, каждая лаборатория имеет свои референтные значения. Впрочем, эти тонкости вряд ли будут интересны читателю…
Далее разберем подробнее основные показатели общего анализа крови и выясним их роль.
Эритроциты в общем анализе крови и их характеристики
Эритроциты или красные кровяные тельца (Эр, Er) – наиболее многочисленная группа клеточных элементов крови, представленная безъядерными дисками двояковогнутой формы (норма у женщин и мужчин разная и составляет 3,8 – 4,5 х/л и 4,4 – 5,0 х/л соответственно). Эритроциты возглавляют общий анализ крови. Имея многочисленные функции (дыхание тканей, регулирование водно-солевого баланса, перенос на своих поверхностях антител и иммунокомплексов, участие в процессе свертывания и др.), данные клетки обладают способностями проникновения в самые малодоступные места (узкие и извитые капилляры). Для осуществления этих задач эритроцитам необходимо обладать определенными качествами: размером, формой и высокой пластичностью. Любые изменения этих параметров, выходящие за норму, показывает общий анализ крови (исследование красной части).
Эритроциты содержат важный для организма компонент, состоящий из белка и железа. Это — красный пигмент крови, называемый гемоглобином. Снижение в крови эритроцитов обычно влечет за собой и падение уровня Hb, хотя существует и другая картина: красных кровяных телец достаточно, но многие из них пустые, тогда и в ОАК будет низкое содержание красного пигмента. Для того, чтобы узнать и оценить все эти показатели, существуют специальные формулы, которыми пользовались врачи до появления автоматических анализаторов. Сейчас подобными делами занимается аппаратура, а в бланке общего анализа крови появились дополнительные графы с непонятной аббревиатурой и новыми единицами измерения:
- RBC – общее количество красных кровяных телец (эритроцитов). Старые люди помнят, что раньше их считали в камере Горяева до миллионов в микролитре (4,0 — 5,0 млн — была такая норма). Сейчас количество измеряется в единицах СИ — тера на литр (10 12 клеток/л). Повышение количества Эр – эритроцитоз может быть связан с психоэмоциональной и физической нагрузкой, что следует учитывать, отправляясь сдавать общий анализ крови. Патологическое увеличение красных клеток – эритремия, как правило, связана с нарушением кроветворения. Пониженные значения показателя (эритропения) возникают при кровопотере, гемолизе, анемии, снижении продукции эритроцитов.
- HGB – это гемоглобин, он представляет собой белок, содержащий железо и измеряется в граммах на литр (г/л), хотя вряд ли стоит останавливаться на подробном описании показателя, поскольку, наверное, нет человека, не знающего о норме гемоглобина (120 – 140 г/л у женщин, 130 – 160 г/л у мужчин) и его главном назначении – транспорте кислорода (оксигемоглобин) к тканям, углекислого газа (карбогемоглобин) от них и поддержании кислотно-щелочного равновесия. Как правило, при снижении данного показателя думают об анемии. Падение гемоглобина ниже допустимого уровня требует всестороннего обследования пациента (поиск причины).
HCT – гематокрит, показатель выражается в процентах. Его можно наблюдать, если оставить в покое флакон с консервированной кровью для спонтанного оседания клеток крови: красная насыщенная часть, осевшая на дно – форменные элементы крови, желтоватая жидкость верхнего слоя — плазма, соотношение между упавшими эритроцитами и общим объемом крови и есть гематокрит. Повышение показателя наблюдается при эритремии, эритроцитозе, шоке, полиурии, снижение уровня – при анемии и увеличении объема циркулирующей крови (ОЦК) за счет увеличения плазмы (например, при беременности).
- MCV (средний объем эритроцитов), выражаемый в фемтолитрах. Аппарат складывает вместе объемы нормоцитов, микроцитов (лилипутов), макроцитов (больших клеток), мегалоцитов (гигантов) и вычисляет среднее значение объема. Показатель служит для определения водно-солевого состояния и типа анемии.
- RDWс — степень разнообразия эритроцитов, показывающая насколько клетки отличаются друг от друга по объему – анизоцитоз (нормоциты, микроциты, макроциты, мегалоциты).
- MCH – (среднее содержание Hb в Эр) — аналог цветового показателя, свидетельствующий о насыщении клеток гемоглобином (нормохромия, гипо- или гиперхромия).
- MCHC (среднее содержание и средняя концентрация кровяного пигмента в красных клетках крови). МСНС коррелирует с такими показателями как MCV и MCH и рассчитывается, исходя из уровней гемоглобина и гематокрита (МСНС ниже нормы в первую очередь может свидетельствовать о гипохромной анемии или талассемии).
Индикатор многих болезней — СОЭ
СОЭ (скорость оседания эритроцитов) считается индикатором (неспецифическим) самых разнообразных патологических изменений в организме, поэтому данный тест практически никогда не обходят стороной в диагностическом поиске. Норма СОЭ находится в зависимости от пола и возраста – у абсолютно здоровых женщин она в 1,5 раза может превышать данный показатель у детей и взрослых мужчин.
Как правило, такой показатель, как СОЭ записывается в низу бланка, то есть, он как бы завершает общий анализ крови. В большинстве случаев СОЭ измеряется за 60 минут (1 час) в незаменимом по сей день штативе Панченкова, правда, в наше высокотехнологичное время есть аппараты, позволяющие сократить время определения, однако далеко не все лаборатории их имеют.
Лейкоцитарная формула
Лейкоциты (Le) — это «разношерстная» группа клеток, представляющих «белую» кровь. Количество лейкоцитов не так велико, как содержание красных кровяных телец (эритроцитов), их нормальное значение у взрослого человека колеблется в пределах 4,0 – 9,0 х 10 9 /л.
В ОАК эти клетки представлены в виде двух популяций:
- Клетки-гранулоциты (зернистые лейкоциты), содержащие гранулы, которые наполнены биологически-активными веществами (БАВ): нейтрофилы (палочки, сегменты, юные, миелоциты), базофилы, эозинофилы;
- Представители агранулоцитарного ряда, которые, однако, тоже могут иметь гранулы, но уже другого происхождения и назначения: иммунокомпетентные клетки (лимфоциты) и «санитары» организма — моноциты (макрофаги).
Самая частая причина повышения лейкоцитов в крови (лейкоцитоз) – инфекционно-воспалительный процесс:
- В острой фазе активизируется и, соответственно, повышается нейтрофильный пул (вплоть до выхода молодых форм);
- Чуть позже в процесс включаются моноциты (макрофаги);
- Стадию выздоровления можно определить по увеличенному количеству эозинофилов и лимфоцитов.
Расчет лейкоцитарной формулы, как указывалось выше, не полностью доверяется даже самому высокотехнологичному оборудованию, хотя его нельзя заподозрить в ошибках — аппараты хорошо и точно работают, дают большой объем информации, значительно превышающий таковой при работе вручную. Однако есть один малюсенький нюанс — автомат пока не в полной мере может видеть морфологические изменения в цитоплазме и ядерном аппарате лейкоцитарной клетки и заменить глаза врача. В связи с этим идентификацию патологических форм все-таки проводят визуально, а анализатору позволяют считать общее количество белых клеток крови и разделять лейкоциты на 5 параметров (нейтрофилы, базофилы, эозинофилы, моноциты и лимфоциты), если в распоряжении лаборатории имеется высокоточная аналитическая система 3 класса.
Глазами человека и машины
Гематологические анализаторы последнего поколения не только способны проводить сложный анализ представителей гранулоцитов, но и дифференцировать клетки агранулоцитарного ряда (лимфоциты) внутри популяции (субпопуляции Т-клеток, В-лимфоциты). Врачи успешно пользуются их услугами, но, к сожалению, подобное оборудование пока является привилегией специализированных клиник и больших медицинских центров. При отсутствии всякого гематологического анализатора количество лейкоцитов можно сосчитать и старым дедовским методом (в камере Горяева). Между тем, читатель не должен думать, что тот или иной метод (ручной или автоматический) обязательно лучше, врачи, работающие в лаборатории, следят за этим, контролируя себя и машину, и при малейшем сомнении предложат пациенту повторить исследование. Итак, лейкоциты:
- WBC – так обозначается количество белых клеток крови (лейкоцитов). Подсчет лейкоцитарной формулы не доверяется никакому аппарату даже cамому высокотехнологичному (III класс), поскольку ему тяжело отличить юные от палочкоядерных и нейтрофилов, для машины все одно – нейтрофильные гранулоциты. Расчет соотношения разных представителей лейкоцитарного звена берет на себя врач, который собственными глазами видит, что происходит в ядре и цитоплазме клеток.
- GR — гранулоциты (в анализаторе). При работе вручную: гранулоциты = все клетки лейкоцитарного ряда – (моноциты + лимфоциты) – повышение показателя может свидетельствовать об острой фазе инфекционного процесса (повышение популяции гранулоцитов за счет нейтрофильного пула). Гранулоциты в общем анализе крови представлены в виде 3 субпопуляций: эозинофилы, базофилы, нейтрофилы, а нейтрофилы, в свою очередь, присутствуют в виде палочек и сегментов или могут появляться, не завершив свое созревание (миелоциты, юные), когда нарушается процесс кроветворения либо иссякают резервные возможности организма (тяжелые инфекции):
- NEUT, нейтрофилы (миелоциты, юные, палочки, сегменты) – эти клетки, обладая хорошими фагоцитирующими способностями, первыми бросаются на защитуорганизмаотинфекции;
- BASO, базофилы (повышение — аллергическая реакция);
- ЕО, эозинофилы (повышение — аллергия, глистная инвазия, период выздоровления).
- MON, Mo (моноциты) – самые крупные клетки, являющиеся частью МНС (мононуклеарной фагоцитарной системы). Они в виде макрофагов присутствуют во всех воспалительных очагах и не торопятся покидать их еще некоторое время после затихания процесса.
- LYM, Ly (лимфоциты) – отнесены к классу иммунокомпетентных клеток, их различные популяции и субпопуляции (Т- и В-лимфоциты) участвуют в осуществлении клеточного и гуморального иммунитета. Повышенные значения показателя указывают на переход острого процесса в хронический или в стадию выздоровления.
Тромбоцитарное звено
Следующая аббревиатура в общем анализе крови относится к клеткам, называемым кровяными пластинками или тромбоцитами. Исследование тромбоцитов без гематологического анализатора – дело довольно трудоемкое, клетки требуют особого подхода к окрашиванию, поэтому без аналитической системы данный тест проводится по необходимости, а не является анализом по умолчанию.
Анализатор, распределяя клетки, подобно эритроцитам, рассчитывает общее количество кровяных пластинок и тромбоцитарные индексы (MPV, PDW, PCT):
- PLT— показатель, свидетельствующий о количестве кровяных пластинок (тромбоцитов). Повышение содержания тромбоцитов в крови называют тромбоцитозом, сниженный уровень квалифицируют как тромбоцитопению.
- MPV — средний объем кровяных пластинок, единообразие размеров тромбоцитарной популяции, выражаемый в фемтолитрах;
- PDW — ширина распределения данных клеток по объему — %, количественно – степень анизоцитоза тромбоцитов;
- PCT (тромбокрит) – аналог гематокрита, выражается в процентах и обозначает долю тромбоцитов в цельной крови.
Повышенный уровень тромбоцитов и изменение в ту или иную сторону тромбоцитарных индексов может свидетельствовать о наличии довольно серьезной патологии: миелопролиферативных заболеваний, воспалительных процессов инфекционной природы, локализованных в различных органах, а также о развитии злокачественного новообразования. Между тем, количество тромбоцитов могут увеличивать: физические нагрузки, роды, хирургические вмешательства.
Снижение содержания данных клеток наблюдается при аутоиммунных процессах, тромбоцитопенической пурпуре, атеросклерозе, ангиопатии, инфекциях, массивных трансфузиях. Небольшое падение уровня тромбоцитов отмечается перед месячными и во время беременности, однако уменьшение их количества до 140,0 х 10 9 /л и ниже уже должно стать поводом для беспокойства.
Все знают, как готовиться к анализу?
Известно, что многие показатели (особенно, лейкоциты и эритроциты) меняются в зависимости от предшествующих обстоятельств:
- Психоэмоциональное напряжение;
- Интенсивная физическая нагрузка (миогенный лейкоцитоз);
- Еда (пищеварительный лейкоцитоз);
- Вредные привычки в виде курения или бездумного употребления горячительных напитков;
- Применение некоторых лекарственных препаратов;
- Солнечная радиация (перед сдачей анализов нежелательно отправляться на пляж).
Никому не хочется получить недостоверные результаты, в связи с этим на анализ нужно идти натощак, на трезвую голову и без утренней сигареты, минут за 30 успокоиться, не бегать и не прыгать. Люди обязаны знать, что в послеобеденное время, после пребывания на солнце и во время тяжелого физического труда в крови будет отмечаться некоторый лейкоцитоз.
Женский пол имеет еще больше ограничений, поэтому представительницам прекрасной половины необходимо помнить, что:
- Фаза овуляции поднимает общее число лейкоцитов, но снижает уровень эозинофилов;
- Нейтрофилез отмечается во время беременности (перед родами и во время их течения);
- Болевые ощущения, связанные с месячными и сами месячные тоже могут вызвать определенные изменения результатов анализа – придется сдавать кровь заново.
Кровь для развернутого анализа крови при условии проведения его в гематологическом анализаторе сейчас в большинстве случаев берут из вены, одновременно с другими анализами (биохимия), но в отдельную пробирку (вакутайнер с помещенным в нем антикоагулянтом – ЭДТА). Существуют и маленькие микроконтейнеры (с ЭДТА), предназначенные для забора крови из пальца (мочки уха, пятки), которыми чаще пользуются, чтобы брать анализы у малышей.
Показатели крови из вены несколько отличаются от результатов, получаемых при исследовании капиллярной крови — в венозной выше гемоглобин, больше эритроцитов. Между тем, считается, что брать ОАК лучше из вены: клетки меньше травмируются, минимизируется контакт с кожными покровами, к тому же, объем взятой венозной крови при необходимости позволяет повторить анализ, если результаты окажутся сомнительными, или расширить круг исследований (а вдруг выяснится, что необходимо сделать еще и ретикулоциты?).
Кроме этого, многие люди (кстати, чаще взрослые), совершенно не реагируя на венепункцию, панически боятся скарификатора, которым прокалывают палец, да и пальцы иногда бывают синие и холодные – кровь добывается с трудом. Аналитическая система, которая производит развернутый анализ крови, «знает», как работать с кровью венозной и капиллярной, она запрограммирована на разные варианты, поэтому легко может «разобраться», что к чему. Ну, а если аппарат не справится, то его заменит высококвалифицированный специалист, который проверит, перепроверит и вынесет решение, полагаясь не только на способности машины, но и на собственные глаза.
Источник: https://sosudinfo.ru/krov/obshhij-analiz-krovi-oak/
chernovsky.ru
Анализ крови общий какие показатели
Главная » Анализ крови » Анализ крови общий какие показатели
Что непосредственно входит в общий анализ крови? Какие показатели крови считаются нормальными?
Такие вопросы мог бы задать каждый, кто когда-либо сдавал кровь на анализ, а это 100 % населения нашей страны.
Современному человеку в течение своей жизни приходится неоднократно сдавать кровь на клинический общий анализ.
Это исследование проводят при любом сколько-нибудь серьезном заболевании и во время плановых медосмотров. Оно входит в любой пакет клинических исследований.
Состав крови
Кровь циркулирует в теле, находясь в границах сосудов и вен, непрерывно поступая туда под действием ритмически сокращающейся сердечной мышцы.
Непосредственно с остальными тканями она не контактирует — этому препятствует гистогематические барьеры.
Интересные факты:
- Приблизительный вес крови от массы тела составляет 7 %;
- Считается, что в человеке весом 60 – 70 килограммов около 5 литров крови;
- Красный цвет человеческой крови придает гемоглобин;
- У некоторых примитивных животных кровь голубого цвета – такой ее делает вещество гемоцианин.
Кровь состоит из двух частей:
- плазмы;
- форменных элементов.
Плазма на 90 % состоит из воды, близкой по составу к морской. Кроме воды, в плазме есть и сухие вещества, главным образом, это белки и соли. Белков в плазме содержится 7-8 %.
Наряду с белками в плазме находятся продукты белкового распада: мочевина и другие. Превышение содержания этих веществ в крови говорит о недостаточной функции почек.
Форменные элементы взвешены в плазме. В крови они должны находиться в определенном процентном соотношении.
Фото:
Общий анализ крови обязательно определяет показатели содержания форменных элементов, любое отклонение свидетельствует о присутствии в организме патологии.
Все форменные элементы имеют общее происхождение и общие свойства, но каждая группа выполняет собственные функции: транспортные, защитные или регуляторные.
Форменные элементы крови отображены в таблице ниже.
| Гемоглобин | Переносчик кислорода, доставляет его из легочных капилляров в каждый орган и каждую ткань тела. |
| Эритроциты | Содержат железосодержащий белок гемоглобин. Уменьшение их количества — опасный симптом, говорящий о внутренних кровопотерях, которые могут оказаться симптомом онкологического заболевания. Одновременное увеличение эритроцитов и гемоглобина говорит загущении крови, потере плазмы, обезвоживании, дефектах сердечной деятельности, патологии развития внутренних органов, воспалениях. |
| Ретикулоциты | Новообразованные молодые эритроциты. |
| Тромбоциты | Бесцветные клетки, отвечают за свертываемость. |
| Лейкоциты | Очищают организм от проникших внутрь микроорганизмов и вирусов. Снижение их числа называется лейкопения, она говорит о низкой сопротивляемости организма, отсутствии иммунитета. Повышенное содержание лейкоцитов — это показатель многих патологических состояний. Лейкоциты повышаются при инфекции, отравлениях, травмах, после операций, при некоторых заболеваниях внутренних органов. |
| Эозинофилы, лимфоциты, базофилы, моноциты | Белые тельца, разновидности лейкоцитов, отвечающие за иммунитет. |
Что определяет общий анализ?
Клинический общий анализ крови состоит из расчета числа гемоглобина, красных и белых телец, кровяных пластинок. Определяется скорость оседания красных телец, подсчитывается лейкоцитарная формула.
СОЭ — самый важный показатель, на который обращают внимание в первую очередь. Ускоренное СОЭ говорит о том, что эритроциты склеиваются друг с другом и оседают быстрее чем обычно.
СОЭ может повыситься после физических нагрузок, от плохого питания, во время беременности.
Уменьшение СОЭ бывает редко, оно может наблюдаться при нарушении работы печени и сердца, а также при некоторых флебологических недугах.
В клинический общий анализ крови входит исследование на красные тельца. Эритроциты оценивают не только в количественном соотношении, но и в и качественном.
В норме среди них должно быть не более 1 % ретикулоцитов (незрелых эритроцитов). Если ретикулоцитов выше 1 %, то это говорит об определенных патологических состояниях, протекающих в организме.
Гемоглобин — это эритроциты, непосредственно переносящие кислород. Нормальные показатели гемоглобина говорят о хорошей кроветворной способности костного мозга.
Повысить уровень гемоглобина помогает полноценное сбалансированное питание. Необходимо, чтобы в организм в сутки поступало не менее 20 миллиграммов железа.
Много железа содержат в себе следующие продукты: красное мясо, гречка, яйца, курага, грецкий орех, гранат. Усвоению железа мешают молочные продукты, помогает — витамин C.
Клинический развернутый общий анализ предполагает выведение лейкоцитарной формулы — лейкограммы. Лейкограмма определяет процентное содержание разных форм лейкоцитов.
Она может быть сдвинута влево или вправо. Если показатели сдвинуты влево, то это говорит о повышенном количестве незрелых элементов в крови.
Видео:
Когда показатели сдвинуты вправо — это говорит об увеличении сегментоядерных элементов, что характерно для мегалобластной анемии, заболеваний почек и печени.
Лейкограмма, определяемая в процессе общего анализа крови, имеет большое значение, так как она дает возможность прогнозировать исход болезни.
Биохимический анализ отличается от общего методикой и целями проведения. Чтобы провести биохимический анализ, у пациента берут на исследование венозную кровь.
Биохимический анализ имеет свою специфику — с его помощью оценивают работу печени, поджелудочной и почек.
Биохимический анализ определяет количество в крови:
- железа и кальция в сыворотке общего белка;
- билирубина;
- холестерола;
- глюкозы;
- азотистых веществ;
- ферментов и некоторых других веществ.
В биохимический анализ крови входят несколько десятков показателей, все их рассчитывать не нужно.
Врач назначит по своему выбору более или менее развернутый анализ, необходимый для уточнения картины заболевания.
Но даже самый развернутый биохимический анализ, так же, как и общий, не дает возможности поставить диагноз — он используется в комплексе с другими способами диагностики.
Общий анализ — нормальные показатели
Общий анализ крови включает в себя, в зависимости от цели исследования, от 7 (обычный) до 30 (развернутый) показателей. Каждый из них должен находиться в определенных пределах.
Гемоглобин. Норма у мужчин 120 – 160 г/л, у женщин – 120 – 140 г/л. Уменьшение — признак анемии, увеличение наблюдается при обезвоженности.
Гематокрит. Норма для мужчин 40 – 45 %, для женщин – 36 – 42 %. Уменьшение содержания гематокрита бывает при кровотечениях, повышенном сгущении крови.
Эритроциты. Норма для мужчин 4-5*10¹² на литр, для женщин – 3-4*1012 на литр.
Цветовой показатель. Норма 0,85 – 1,05. Нарушение говорит об анемии.
Лейкоциты. Норма 3 – 8*10 9/литр. Повышенное количество лейкоцитов говорит об инфекции или лейкозе, пониженное — об иммунных проблемах.
Нейтрофилы. Норма до 70 % общего числа лейкоцитов. Превышение свидетельствует о гнойном воспалении.
Особенно настораживающе выглядит нормальное содержание нейтрофилов при выраженном гнойном процессе.
Эозинофилы. Норма 1 – 5 % от общего числа лейкоцитов. Превышение этого показателя характерно для глистных инвазий.
Лимфоциты. Норма 19 – 30 %
Тромбоциты. Норма 175 – 322*108, понижение говорит о проблемах с иммунитетом или сильном воспалении.
СОЭ – норма для мужчин 10 мм/ч, для женщин – 15 мм/ч. Превышение этих показателей – очень тревожный знак, который говорит о выраженном воспалении какого-либо органа.
Как проводят процедуру?
Общий анализ крови назначается, если пациент жалуется на слабость, утомляемость, если у него повышенная температура тела.
Также общий анализ могут назначить для отслеживания влияния на кровь некоторых медикаментов.
Метод не требует особенной подготовки. Больной должен прийти натощак, между последним приемом еды и отбором крови на анализ проходит от 8 до 12 часов.
Для исследования берут биожидкость из капилляров, отбирая ее из безымянного пальца (иногда из среднего или указательного).
За 24 часа до сдачи анализа из рациона исключают алкоголь, медикаменты, за 30 минут до забора нельзя курить.
Прокалывают боковую поверхность последней фаланги, для чего наносят туда укол стерильным скарификатором. Предварительно место укола обрабатывают спиртовым раствором.
Первую каплю удаляют ватным шариком, а следующие капли отбирают для исследования, набирая с пальца в стерильную пипетку.
Из крови приготавливают мазки, затем наполняют ею стеклянный капилляр — это нужно, чтобы определить скорость оседания эритроцитов и оценить другие показателем. Мазок крови изучается под микроскопом.
Важно! Нельзя растирать палец перед забором, потому что это приводит к изменению количества лейкоцитов. Также после растирания в крови изменяется соотношение между жидкой и твердой фазой.
Общий, а если нужно, то и биохимический анализ крови назначается на первой стадии любого медицинского обследования.
Эти исследования не могут показать, какой конкретно орган болен, но они отражают патологические изменения организма в целом.
Общий и развернутый биохимический анализы крови — надежные помощники в первичной диагностике инфекций, воспалений.
Они нужны для оценки эффективности проводимого лечения и определения степени тяжести состояния больного.
moydiagnos.ru
Как правильно читать результаты общего и биохимического анализа крови?
Результаты анализов крови показывают общую картину, какое состояние здоровья у конкретного человека. Во всех обследованиях этот вид анализа обязательно присутствует. Конечно, расшифровывать его должен врач, но и пациенту было бы неплохо узнать, какие показатели биохимического анализа крови, и, разумеется, общего, существуют, что они могут означать, как связаны и коррелируют между собой и т.д. В этой статье вы узнаете обо всех показателях общего и биохимического анализа крови, а также о том, какая норма предусмотрена для каждого из них.
Показатели общего анализа крови
Общий анализ крови (который так же многим из нас знаком, как клинический) берется из крови пальца или вены. Исследование такого биологического материала проводится с утра натощак, или в течение дня, но при условии, что человек не ел и не пил 2 часа перед забором крови.
В различных лабораториях бланки, таблицы результатов могу отличаться, но сами нормальные показатели всегда одинаковые. В этой статье будут представлены показатели российского стандарта, которые встречаются в большинстве государственных и частных медицинских учреждений.
Прочесть результаты общего анализа крови взрослый человек может просто, потому что в каждом бланке есть графа, где принято указывать стандартный показатель нормы, и графа полученных индивидуальных результатов. Достаточно только сравнить их. Но! Большинство людей, увидев, что результат отличается от нормы, начинают паниковать. Этого делать нельзя, потому что таким явлениям есть масса причин, например, повышенный гемоглобин встречается у людей, которые мало пьют воды, или повышенное количество лейкоцитов часто встречается у тех, кто занимается спортом или фитнесом из-за физических нагрузок. А у тех, кто курит или принимает оральные контрацептивы, может быть понижен гемоглобин и повышено количество тромбоцитов. Т.е. это также варианты нормы. Поэтому так важно идти именно в больницу с результатами исследований, чтобы расшифровка и оценка показателей была проведена квалифицированным специалистом. Люди с медицинским образованием знают обозначение каждого анализа, а потому умеют правильно их «читать», учитывая все факторы.
Итак, предлагаем вашему вниманию: таблица показателей ОАК (общего анализа крови).
| Показатели | Описание | Норма |
| RBC (red blood cells),эритроциты | Красные кровяные тельца. Показывают, насколько хорошо клетки «дышат». | Для женщин — 3,5-5х штук на 1 л. Для мужчин 4,5-5х штук на 1 л. Ниже нормы — анемия, нехватка кислорода.
Выше нормы — слишком густая кровь, риск закупорки сосудов. |
| HGB (Hb), гемоглобин | Гемоглобин транспортирует кислород к клеткам. | Для женщин 120-160 г/л. Во время беременности или менструации допустимо 110-120. Для мужчин — 130-170 г/л. Ниже нормы — анемия, нехватка кислорода.
Выше нормы — повышенное количество эритроцитов. |
| НСТ, гематокрит | Соотношение красных и белых телец в крови (процент содержания красных). | Для женщин — 0,36-0,46%. Для мужчин — 0,41-0,53%. Выше нормы — сгущение крови.
Ниже нормы — анемия. |
| PLT (platelets), тромбоциты | Тромбоциты отвечают за свертываемость крови. | Для женщин и мужчин одинаковый — 180-360 х 109 на л. Выше нормы — варикоз, тромбоз.
Ниже нормы — проблемы в системе кроветворения. |
| L, WBC (white blood cells), лейкоциты. | Белые кровяные тельца обеспечивают иммунную защиту. | Для женщин и мужчин одинаков — 4-9 х 109 на л. Выше нормы — воспаления, вирусы, бактерии, грибки, кровопотери.
Ниже нормы — некоторые вирусные заболевания. |
| ESR, СОЭ, скорость оседания эритроцитов | Непрямой показатель воспалительного процесса. | Для женщин — 12-20 мм/ч в зависимости от возраста. Для мужчин — 8-15 мм/ч в зависимости от возраста. Выше нормы — возможные воспаления.
Ниже нормы — редкий случай. |
Показатели биохимического анализа крови
Биохимический анализ крови намного сложнее, и назначается он при подозрении на какое-либо заболевание. Также врачи рекомендуют его сдавать в качестве профилактического анализа при комплексном обследовании организма. Данный вид анализа показывает, насколько хорошо работают органы – печень, поджелудочная железа, почки, сердце и т.д. Кровь берется только из вены через 6-12 часов после приема пищи, т.е. оптимальным будет забор крови утром натощак. Здесь также нужно учитывать индивидуальные особенности. Например, повышенное содержание мочевины можно встретить после занятий спортом.
Таблица показателей биохимического анализа крови.
| Показатели | Описание | Норма |
| Уровень сахара в крови (глюкоза) | Все углеводы в конечном счете превращаются в глюкозу и поступают в кровь. По тому, насколько быстро глюкоза выходит из крови, благодаря гормону инсулину, можно судить о некоторых патологиях. | Для женщин и мужчин одинаков — 3,3-6,1 мм/л. Ниже нормы — гипогликемия из-за голода, диеты, физической нагрузки.
Выше нормы — сахарный диабет. |
| Мочевина | В процессе переваривания белка образуется аммиак, который забирает в себя мочевина и выводит через почки. | Для женщин и мужчин одинаков — 2,5-8,3 мм/л. Ниже нормы — беременность, лактация, дефицит белка.
Выше нормы — почечная недостаточность. |
| Креатинин | Продукт обмена белков в комплексе с мочевиной. Показывает работу почек. | Для женщин — 53-97 мкмоль/л. Для мужчин — 62-115 мкмоль/л. Выше нормы — гипертиреоз или почечная недостаточность.
Ниже нормы — голодание, вегетарианство, прием кортикостероидов. |
| ОХ — общий холестерин, ЛПНП — липопротеин низкой плотности, ЛПВП — липопротеин высокой плотности. | Уровень жира. ЛПНП показывает риск развития атеросклероза, ЛПВП — очищает сосуды. | ЛПНП: Для женщин — 1,92-4,51 ммоль/л. Для мужчин — 2,25-4,82 ммоль/л. ЛПВП: Для женщин — 0,86-2,28 ммоль/л. Для мужчин — 0,7-1,73 ммоль/л.
Любые отклонения свидетельствуют о проблемах с ССС или печени. |
| ТГ, триглицериды | Уровень их содержания может показывать наличие атеросклероза или указывать на риск развития ожирения. | Для женщин — 0,41-2,96 ммоль/л. Для мужчин — 0,5-3,7 ммоль/л. Выше нормы — тромбоз, гепатит, панкреатит, заболевания ССС.
Ниже нормы — гипертиреоз, травмы, заболевания легких в хронической форме. |
| Общий (ОБ), прямой (ПБ) и непрямой билирубин (НБ) | Билирубин — продукт распада гемоглобина, образует желчь, а потому должен отвечать и демонстрировать качество работы печени. | ОБ — 3,4-17,1 мкмоль/л. ПБ — 0-3,4 мкмоль/л. Выше нормы — проблемы с печенью.
Ниже нормы — гипобилирубенимия. |
Кроме представленных в таблице показателей, могут также встретиться и следующие:
- Аланинаминотрансфераза (АЛТ, АЛАТ) и аспартамаминотрансфераза (АСТ, АЛАТ) – это маркеры печени и сердца, показатели которых одинаковы: у мужчин – до 41 Ед/л, у женщин – до 31 Ед/л. Повышенное содержание АСТ говорит о проблемах с печенью, повышенное содержание АЛТ говорит о проблемах с сердцем.
- Амилаза и липаза – ферменты поджелудочной железы. Амилаза отвечает за переваривание углеводов, липаза – жиров. Норма амилазы составляется 28-100 Ед/л, липазы – 0-190 Ед/л. Если показатели завышены, это говорит о воспалительных процессах в поджелудочной железе, или о ее повреждении.
- Фосфатаза щелочная – маркер работы печени, желчевыводящих путей, состояния костей. У женщин норма составляет до 240 Ед/л, у мужчин – до 270 Ед/л. Завышенные или заниженные показатели этого маркера говорят о многих патологиях: заболевания печени, щитовидной железы, менопаузе, недостатке кальция, избытке витамина С и т.д.
Как распознать инфекцию по анализу крови?
Чтобы определить точный диагноз при подозрении на различного рода инфекции, воспаление, закисление организма, онкологию нужно сдать общий анализ крови с лейкоцитарной формулой. В результатах будут указаны следующие показатели:
- Нейтрофилы. Клетки, которые убивают токсины и бактерии. В норме у здоровых людей составляют 47-78%. Повышенные показатели свидетельствуют о воспалительных процессах, инфекции. А если организм будет содержать пониженное число клеток, это говорит о наличии вирусов, грибке, хронической инфекции, простейших, вроде токсоплазмоза.
- Лимфоциты. Эти главные регуляторы человеческого иммунитета известны, наверное, всем. В норме они составляют 19-37%. Любые инфекции, а также некоторые состояния организма, например, менструация повышают этот показатель. При иммунодефиците и приеме кортикостероидных препаратов показатель сильно занижается.
- Гранулоциты. В эту группу также отдельно входят: эозинофилы, моноциты и базофилы. Норма у эозинофилов составляет 0,5-5,0 %. Аллергия, астма, прием антибиотиков, гельминты повышают показатель. Моноциты в норме составляют 3-11 %. Повышенное содержание говорит о венерических заболеваниях, заражениях простейшими, туберкулезе. Базофилы в норме составляют 0-1 %. Повышенное содержание говорит об аллергии, воспалительных процессах в ЖКТ, гормональных нарушениях.
Поделиться:
Нет комментариев
www.ladygym.ru
Какие показатели входят в общий (клинический) анализ крови
- доступное, оно проводится в каждом государственном и частном ЛПУ, и по цене, приемлемой для любого кошелька,
- выполняется в кратчайшие сроки — сутки, а если стоит отметка CITO! – срочно – в течение 1,5 – 2 часов,
- информативное.
- Тройки: Hb – гемоглобин, Le – лейкоциты, СОЭ – скорость оседания эритроцитов.
- Развернутого анализа с лейкоцитарной формулой.
- Гемоголобин.
- Эритроциты.
- Цветовой показатель.
- Ретикулоциты.
- Тромбоциты.
- Лейкоциты: палочкоядерные, сегментоядерные, эозинофилы, базофилы, лимфоциты, моноциты.
- СОЭ.
Показатели крови
- Гемоглобин.
- Эритроциты.
- Тромбоциты.
- Лейкоциты.
- СОЭ.
- Клинический анализ крови: что показывает
Гемоглобин
- красном мясе,
- свиной и говяжьей печени,
- гречке,
- кураге,
- орехах,
- черном изюме,
- гранате,
- абрикосах.
- Массивных внутренних и наружных кровотечениях.
- Хронических внутренних кровотечениях при миомах матки, язве желудка, двенадцатиперстной кишки, эрозивно-язвенных колитах.
- Нарушениях кроветворной функции.
Эритроциты
Тромбоциты
- Тромбоцитоз: что это такое
- воспалительном процессе,
- инфекционном,
- отравлении,
- травме,
- каком-либо заболевании внутренних органов,
- либо лейкозе.
- Эозинофилов.
- Лимфоцитов.
- Базофилов.
- Моноцитов.
- Палочкоядерных и сегментоядерных клеток.
- Клинический анализ крови с лейкоцитарной формулой
Лимфоциты
Базофилы
Моноциты
СОЭ
- Общий анализ крови при раке
pro-analiz.ru
Показатели общего анализа крови у взрослых: что в него входит и как сдавать
К сожалению, люди часто считают, что ходить к врачам им некогда. А зря. Требуется хотя бы примерно понять происходящие изменения, если с организмом творится что-то не то. Для этого нужны элементарные анализы. Один из них — общий анализ крови.
Примечание. Более правильно с точки зрения медицинской науки именовать данное исследование термином «клинический анализ крови». Клинический — потому что это первое, с чего начинают обследование на любое заболевание в клинике.
Основные показатели крови
Цель общего анализа крови — посмотреть клеточные показатели крови с целью общей первоначальной оценки иммунитета, свертывания и способности переносить кислород к тканям.
Техника сдачи крови и подготовка к анализу
Многие пациенты задаются вопросом: сдавать анализ натощак или нет? Конечно, любой анализ крови лучше сдавать натощак. Это увеличивает достоверность показателей. Однако если человек поел или сдал кровь не с утра, а днем или вечером, все равно результаты исследования должны быть в пределах нормы.
Важно! При отсутствии патологии, в какое бы время суток и после приема какой пищи анализ крови не взяли, цифровые показатели всегда будут в пределах референсных (нормальных) значений.
Осуществить забор крови на клинический анализ можно двумя путями:
- Из пальца. Старый и проверенный метод, когда, надавливая иглой, прокалывают подушечку пальца и «выжимают» нужное количество крови в узкую мензурку или длинную пипетку. Затем каплю крови размазывают по предметному стеклу для срочного изготовления мазка.
Примечание. Осмотр мазка крови под микроскопом — это то, что входит в клинический анализ крови обязательно.
Недавно выяснилось, что данный метод забора имеет существенный недостаток. При взятии анализа в кровь выбрасываются белковоподобные вещества, образующиеся при повреждении тканей от прокола. Это может исказить результаты исследования, поскольку нынешние анализаторы очень чувствительные. И еще: пальцы, откуда берут зачастую кровь в поликлинике лаборанты, снабжены огромным количеством капилляров. Капиллярная кровь имеет несколько другие показатели, нежели венозная. А достовернее данные все же у венозной крови.
- Из вены. Его делают обычно вместе с биохимическим. Достовернее те данные, что показывает общий анализ крови из вены, поскольку венозная кровь наиболее приближена к показателям гомеостаза (постоянства) организма.
Важно! Таким образом, есть один вариант, как правильно сдавать анализ крови: натощак и из вены.
Специфическая подготовка при направлении больного на общий (клинический) анализ крови не нужна. Главное — правильный забор и адекватная оценка показателей.
Из этой видео-передачи «Жить здорово» вы узнаете о важных показателях в общем анализе крови
Трактовка результатов
Понятно, что параметры анализа крови у каждого совершенно разные и сугубо индивидуальны. Но норма для всех находится в определенных границах, указанных ниже.
| Общий анализ крови (норма) | ||
| Показатель | Взрослые женщины | Взрослые мужчины |
| Гемоглобин | 120–140 г/л | 130–160 г/л |
| Эритроциты | 3,7—4,7×1012 | 4—5,1×1012 |
| Цветовой показатель | 0,85–1,15 | 0,85–1,15 |
| Регакулоциты | 0,2–1,2% | 0,2–1,2% |
| Тромбоциты | 180—320×109 | 180—320×109 |
| соэ | 2–15 мм/ч | 1–10 мм/ч |
| Лейкоциты | 4—9×109 | 4—9×109 |
| Палочкоядерные | 1–6% | 1–6% |
| Сегментоядерные | 47–72% | 47–72% |
| Эозинофилы | 0–5% | 0–5% |
| Базофилы | 0–1% | 0–1% |
| Лимфоциты | 18-40% | 18-40% |
| Моноциты | 2–9% | 2–9% |
Таблица: Оптимальные показатели клинического анализа крови у взрослых
Общий гематологический анализ крови бывает 2 видов:
- Так называемый экспресс-анализ, когда смотрят только количество тромбоцитов, лейкоцитов и эритроцитов, гемоглобин игематокрит.
- Развернутый анализ крови. Помимо количественного значения клеточных показателей делают СОЭ (раньше была аббревиатура «РОЭ», но это неправильно, верный термин — «скорость оседания эритроцитов»), вычисляют средний объем эритроцита (MCV), распределение тромбоцитов по объему и насыщенность эритроцита гемоглобином.
Изучите материал о том, что делать, если гематокрит у взрослого повышен и проведите необходимое лечение.
После забора крови и изготовления мазка лаборантом врачом производится расшифровка анализа крови. Общий смысл таков:
- определить выраженные отклонения от нормальных (референсных) значений;
- обратить внимание на показатели, близкие к верхним и нижним границам нормы;
- составить ориентировочное заключение по крови;
- обозначить дальнейший план обследования больного.
Забор крови из пальца
Примечание. Сколько делается клинический анализ крови — зависит от конкретной лаборатории, но в целом не более 3-4 суток.
Основные причины колебания клеточных показателей крови
Лейкоциты
Снижение лейкоцитов происходит при:
- раке костного мозга (различные виды лейкозов — с лейкоцитарной формулой, сдвинутой влево, т.е. в периферической крови обнаруживаются бластные структуры);
- ВИЧ-инфекции (чаще — в стадии СПИДа);
В этом случае необходимо сдать анализ крови на ВИЧ, который поможет подтвердить или исключить данное заболевание.
- затяжном и генерализованном инфекционном процессе (последние стадии сепсиса, остеомиелита);
- лучевой болезни;
- последствиях химиотерапии и лучевой терапии (лечение злокачественных опухолей).
Повышение лейкоцитов случается, если имеет место:
- любой инфекционно-воспалительный процесс. А если он переходит в хроническую форму, то повышены и лимфоциты;
- аллергические реакции;
- инвазии глистов (гельминтозы);
Важно! При аллергиях и наличии в организме гельминтов обращает на себя внимание сильное повышение одной фракции лейкоцитов — эозинофилов.
- системные заболевания (красная волчанка, склеродермия, болезнь Крона, саркоидоз и др.);
- первые стадии онкологических заболеваний.
Эозинофилы в слизистой бронха
Тромбоциты
Показатель повышается, если есть:
- истинная полицитемия. Происходит активация в костном мозге всех ростков кроветворения, в т.ч. тромбоцитарного;
- последствия воспалительных заболеваний (кишечная инфекция, тяжелое ОРВИ, пневмония и др.). В период выздоровления и далее в течение 2-3 месяцев будет тромбоцитоз;
- злокачественные опухоли;
- отсутствие селезенки;
- аутоиммунные заболевания;
- прием гормональных контрацептивов.
Совет! У женщин при приеме эстрогенсодержащих препаратов необходимо хотя бы один раз в квартал делать общий анализ крови с целью контроля тромбоцитов как клеточного фактора свертывания.
Количество тромбоцитов снижается при следующих заболеваниях (состояниях):
- врожденные патологии (тромбоцитопеническая пурпура Шенлейн-Геноха);
- панцитопенические состояния (рак крови, метастазы в кости и костный мозг);
- заболевания печени (гепатиты, жировая или алкогольная дистрофия, циррозы);
Патологии печени, способствующие тромбоцитопении
- последствия кровопотери;
- В12-дефицитная анемия;
- прием глюкокортикоидов и антибиотиков;
- гиперспленизм (повышенное и интенсивное разрушение тромбоцитов в селезенке).
Эритроциты
Красные кровяные клетки снижены при:
- анемиях различного генеза;
- тяжелой инфекции;
- опухолях любых локализаций;
- приеме препаратов (транквилизаторов и нейролептиков, иммунодепрессантов);
- беременности;
- кровотечениях разной локализации.
При повышенном количестве эритроцитов может развиваться такое заболевание крови как Эритремия, подробная информация о которой имеется на нашем портале.
Важно! Эритропения — это зачастую единственный признак какого-либо постоянного, хронически продолжающегося внутреннего кровотечения.
Эрозивный гастрит и язва желудка — наиболее частые причины внутреннего кровотечения
Эритроциты повышены, если имеет место:
- эритремия (врожденное заболевание костного мозга с активацией эритроцитарного ростка);
- прием анаболиков и допинга (чаще это препараты эритропоэтинового ряда);
- сгущение крови при потерях жидкости (понос, рвота, профузные поты);
- нарушения функции дыхания вследствие хронических заболеваний или недостатка кислорода во внешней среде (например, в горах).
Примечание. При обструктивных болезнях легких эритроциты повышаются как компенсаторная реакция на недостаточное насыщение тканей кислородом.
Любые изменения в анализе крови — серьезный повод для детального обследования организма, дабы предотвратить беду.
Рекомендуем изучить похожие материалы:
- 1. Система гемостаза: зачем сдавать анализ на свёртываемость крови
- 2. Аутоиммунная гемолитическая анемия у детей: чего не хватает и как проявляется
- 3. Как подобрать диету по группе крови: худеем вместе
- 4. Понизился уровень базофилов у взрослых: как лечить базофилию
- 5. Причины повышения или понижения нейтрофилов в анализе крови у детей?
- 6. Нормы содержания нейтрофилов в крови и какие функции они выполняют
- 7. Что значат повышенные эозинофилы в анализе крови у взрослых?
moyakrov.ru
www.medhelp-home.ru
Общий анализ крови. Показатели.
Общий анализ крови, он же клинический анализ крови, является одним их самых наиболее назначаемых. Данное лабораторное обследование проводится практически при любом заболевании или патологическом состоянии. Популярность общего анализа крови обусловлена его информативностью. Информативность, а соответственно и значимость, обуславливают показатели, которые входят в состав общего анализа крови.
Показатели общего анализа крови
Почему же именно эти показатели вошли в общий анализ крови?
Для ответа на этот вопрос необходимо вспомнить функции крови. Одними из самых главных функций крови являются:
- Дыхательная, т.е. перенос кислорода гемоглобином, который входит в состав эритроцитов, от легких к тканям, и перенос углекислого газа от тканей к легким. Именно поэтому, определение гемоглобина и эритроцитов, а также гематокрита и цветового показателя в крови имеет огромное значение, и входит в общий анализ крови.
- Защитная, или иммунная. В крови циркулируют иммунные клетки, которые после выхода из красного костного мозга перемещаются в ткани. Именно поэтому определение общего количества лейкоцитов и определение всех разновидностей лейкоцитов, т.е. эозинофилов, базофилов, нейтрофилов, моноцитов и лимфоцитов, также имеет огромное значение. СОЭ крови, несмотря на свою неспецифичность, при наличии воспалительного процесса, помогает определиться в выраженности воспаления и помогает определить динамику процесса на фоне проводимого лечения.
- Поддержание гемостаза. Свертываемость крови является составной частью гемостаза. Ключевую роль в свертывании крови играют тромбоциты, недостаток которых негативно отражается на гемокоагуляции. Именно поэтому определение количества тромбоцитов в общем анализе крови имеет также большое значение.
medzeit.ru